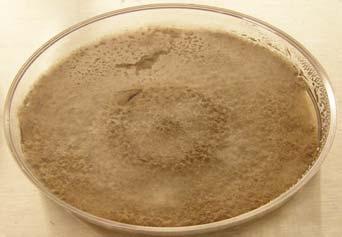
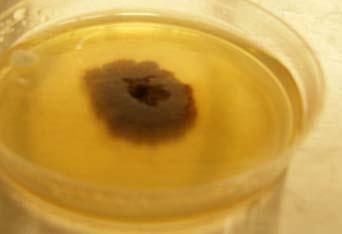
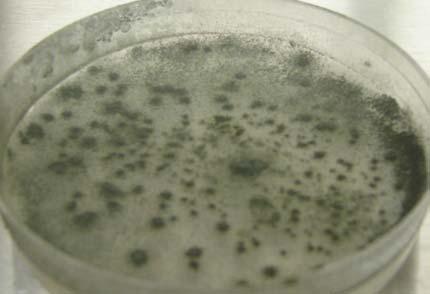
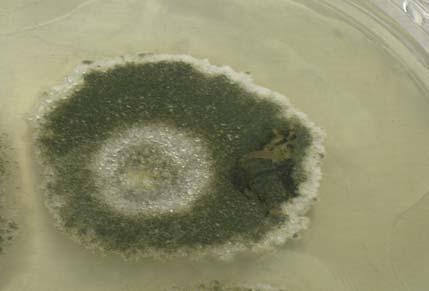
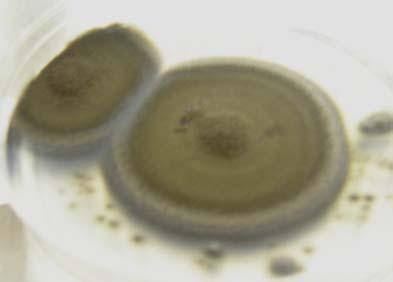
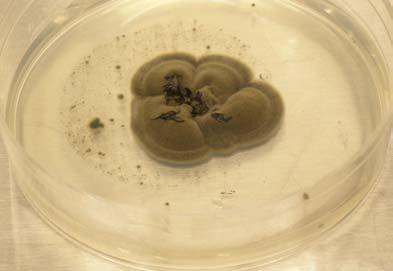
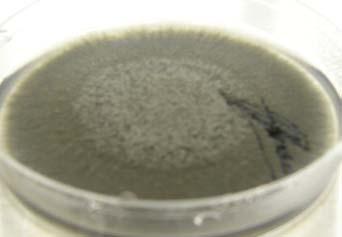
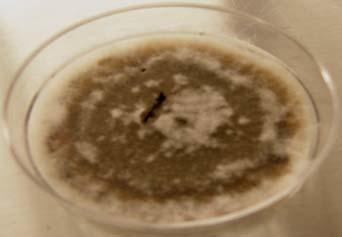
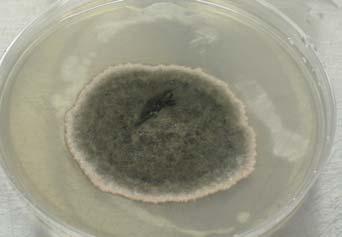
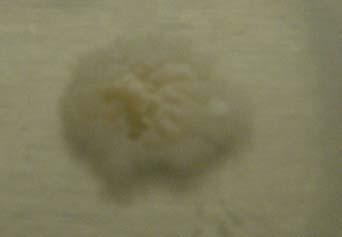
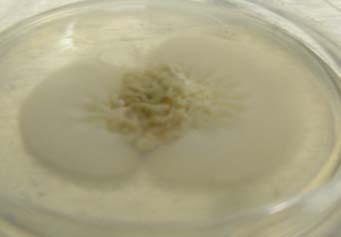
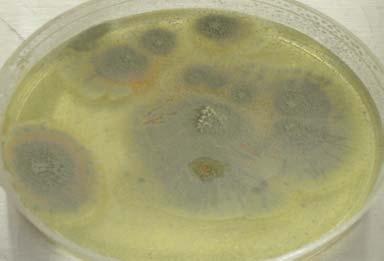
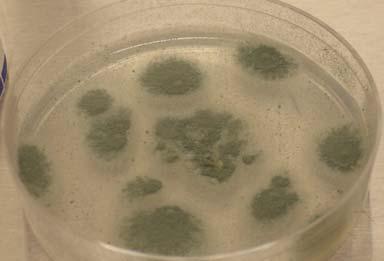
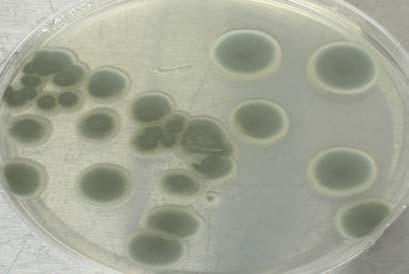
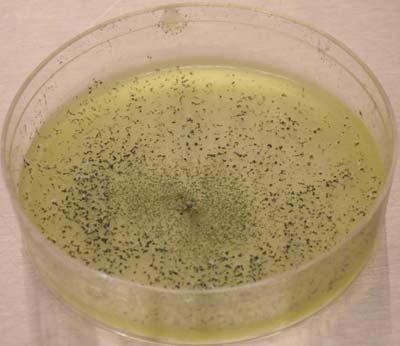
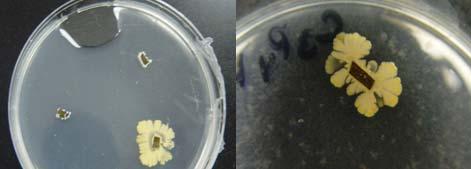
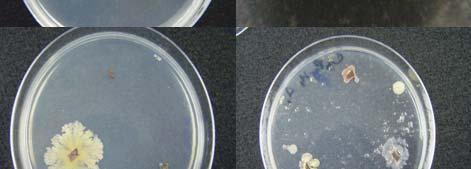
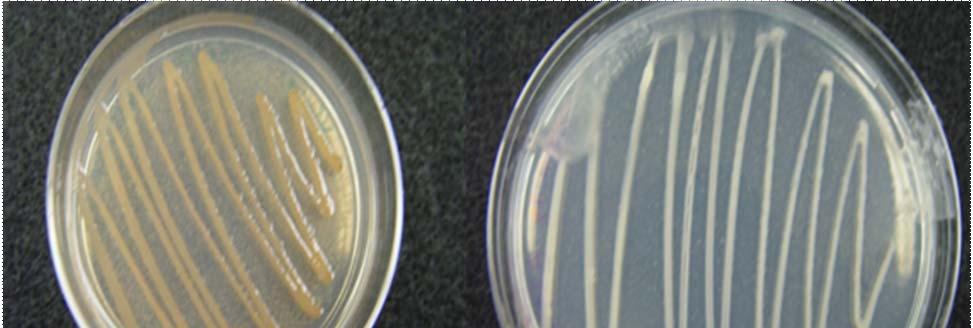
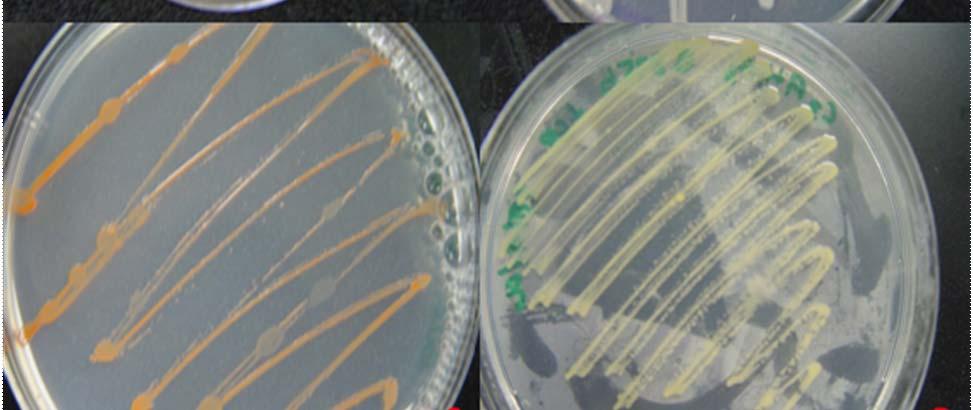
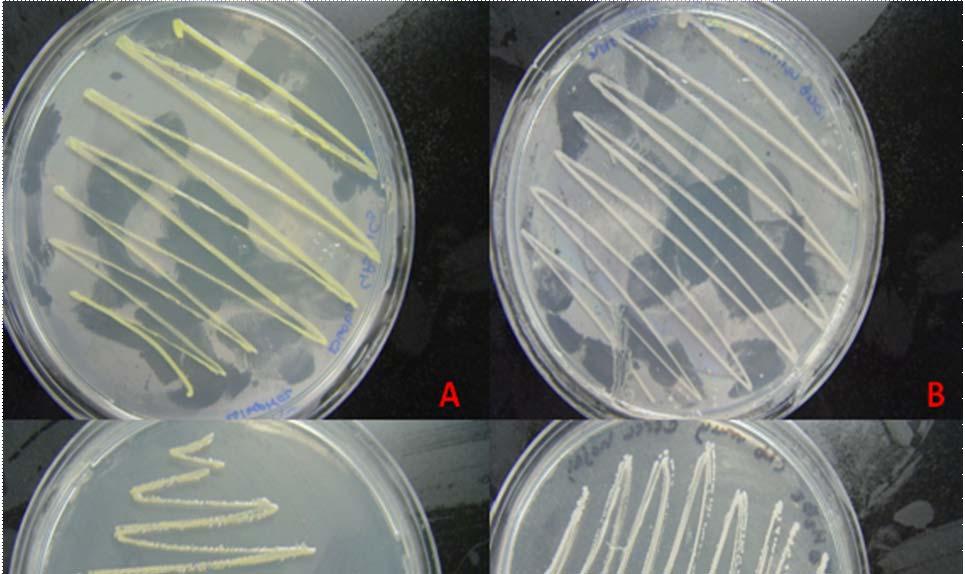
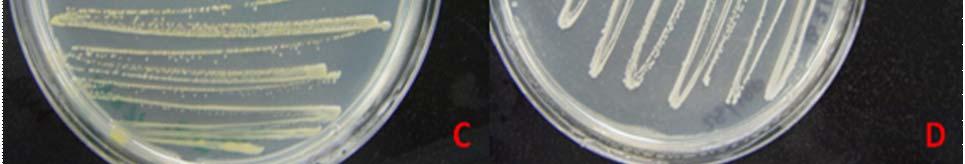
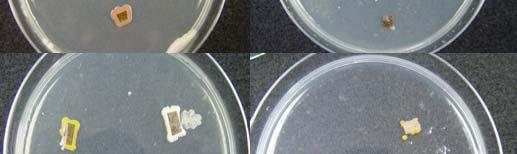
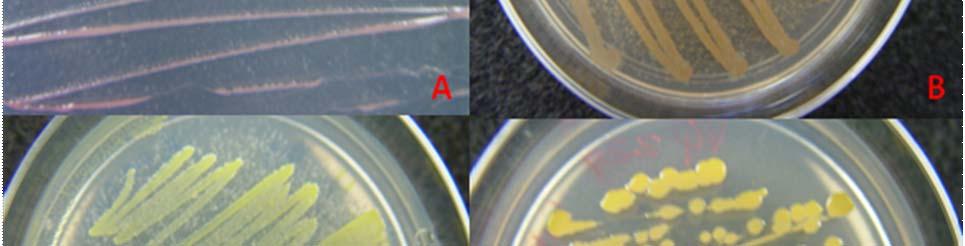
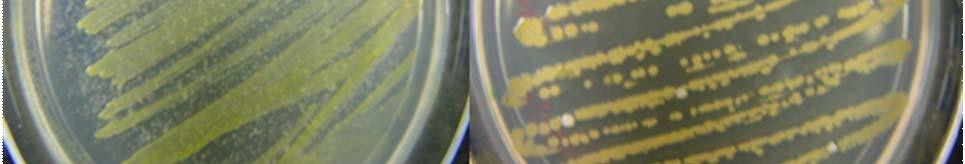
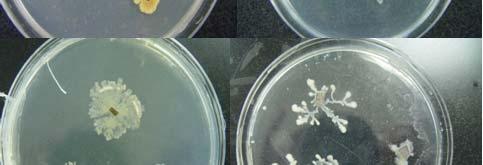
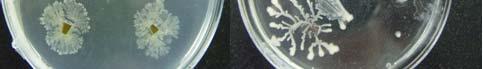
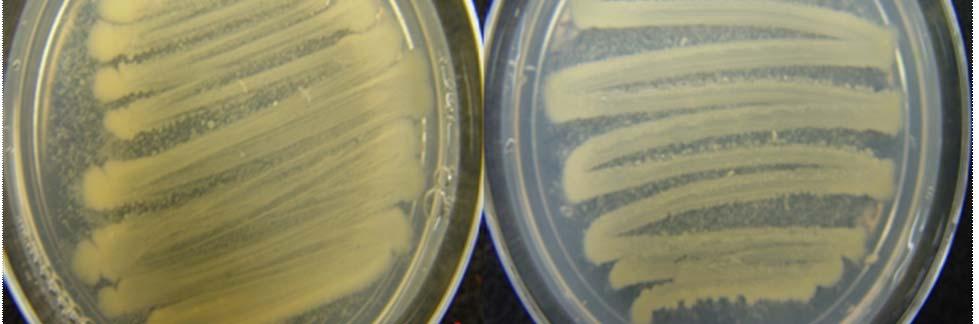
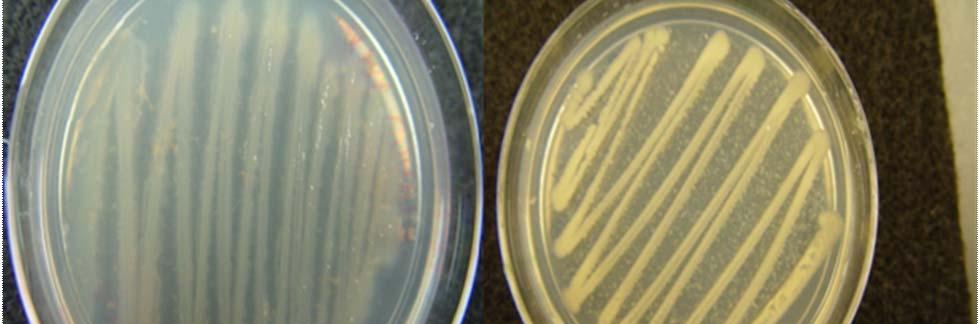
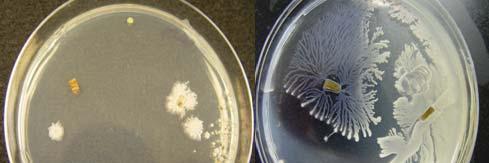
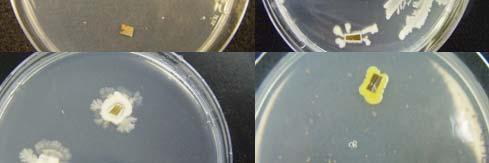
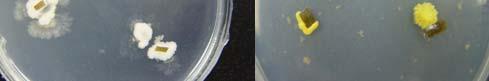
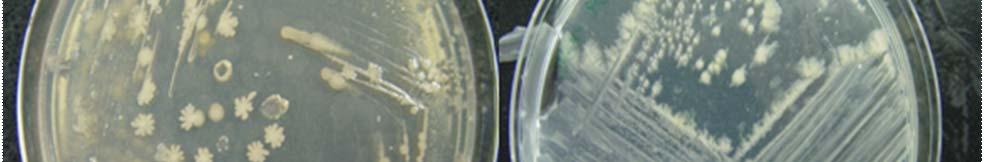
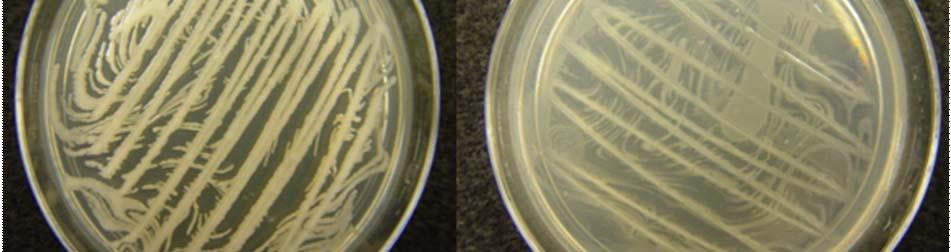
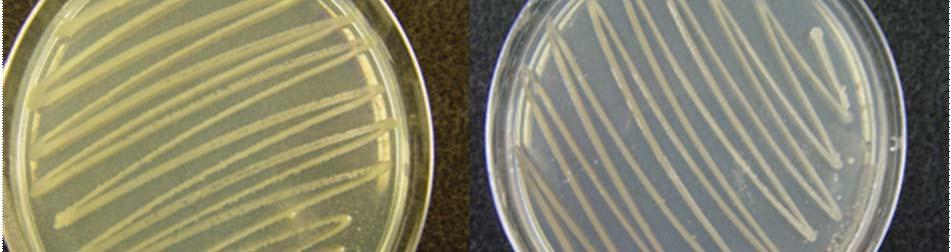

FINAL REPORT NARRATIVE
Sandra L. Maldonado Ramírez (PI) and Rafael Montalvo Rodríguez (Co-PI)
Department of Biology, PO Box 9012, University of Puerto Rico, Mayagüez Campus, Mayagüez, PR 00681-9012
PROBLEM
Research in terrestrial plants has provide evidence that endophytic microorganisms can provide their hosts diverse benefits, including tolerance to salt and drought, seed vitality, enhanced resistance to herbivores and pathogens, and even solubilization of phosphorus and nitrogen. In the sea grass bed ecosystem the information related to the temporal and spatial distribution, host specificity, seasonality of the endophytic flora inhabiting healthy tissue, and the role of the endophytic microflora associated with the host does not exist. We proposed to gather this data sampling four different sites in Puerto Rico with different anthropogenic activity histories to provide this information and to propose new tools for restoration efforts and ecosystem management.
METHODS USED
Study areas: We collected a total of 120 plants of Thalassia testudinum during the extension of this research. Samples were collected twice (fifteen samples at each sampling event) from Buyé Beach and Los Morillos in Cabo Rojo, Cayo Enrique in Lajas, and Puerto de la Libertad in Vieques (Fig. 1).











Fig. 1. Location of sea grass beds of Thalassia testudinum evaluated. Maps were obtained from http://maps.google.com.
Buyé Beach (N18º2’25” W67º12’22”) is characterized by white sands and rocky shores, coral reefs, and sea grass beds. The beach has been impacted intensively by various anthropogenic activities that include thousands of bathers, small boats, marine motorcycles, and occasionally floating houses. Also, in the last twenty years, hotel complexes were constructed in the marine-terrestrial zone. Although we selected an area secluded from bathers and boating activities, at both sampling events people in small boats anchor near the sampling site.
Los Morillos (N17º56’5” W67º11’7”) comprise 1,249 acres of diverse ecosystems (mangroves, hypersaline ponds, marine lagoons, dry forest, coral reefs, and sea grass beds). The area was identified as category 1 by the Fish and Wildlife Service, due to its unique and irreplaceable value at national and regional level. The ecological importance of this area as a feeding ground for endangered and threatened species such as Trichechus manatus manatus and it is also an important habitat for the Queen Conch (Strombus gigas). The main anthropogenic impact in this area has been the commercial extraction of salt. Also, the marine ecosystems have been impacted by the construction of hotels and restaurants in the area, as well as by bathers, local fishermen, and marine sport enthusiasts.
Cayo Enrique (N17º57’12” W67º2’48”) reef is located 1.6km from shore of La Parguera in Lajas that has been impacted severely by aquatic motorcycles, cargo ships, private boats, and floating houses. In a nice summer day, hundreds of boats could be seen anchor to the roots of the mangrove trees, resting over the sea grass beds. Usually bathers enjoy a good swim in the area, trampling over the sea grasses. Also the area historically has been designated a good fishing spot and has been impacted by oil spills occasionally.
The sea grass bed sampled at Puerto de la Libertad (N18º6’7” W65º26’45”) in Vieques is located in the Northwest coast and comprises approximately 4, 225 acres. The sampling site is part of a tranquil, almost secluded beach at the left of the breakwater where a new port will be habilitated for the ferry and for cargo ships. The area is visited by scuba divers and local fishermen and during our second sampling, campers were enjoying a long weekend just few feet away the seashore. In the past, the US military used the current port facilities for ammunition disembarkation and for military practices. The area is currently one of the two components encompass in the Western Vieques Conservation Area, as identified in the 1983 Memorandum of Understanding (MOU) between the Commomwealth of Puerto Rico and the Secretary of the Navy. The ecological importance of this area as a feeding ground for endangered and threatened species such as Chelonia mydas, Trichechus manatus manatus, and Pelecanus occidentalis occidentalis was recognized in the 1983 MOU. It is also an important habitat for the Queen Conch (Strombus gigas) and other species of commercial and recreational value.
Sample collection: At each sampling site we establish three quadrants (10x30m). Using a shovel to loose the sediment, fifteen samples of T. testudinum (five from each quadrant) were collected separately with sediment in sterile, labeled plastic bags. The bags containing the samples were storage in a cooler to maintain the temperature of the samples and processed under aseptic conditions within three hours after collection.
Salinity and temperature data was recorded at the sampling sites. Leaves from the same plants were collected for isolation of prokaryotic endophytes.
Surface sterilization and sample processing: From each individual plant of T. testidinum we selected two leaves with no evident sign of damage or disease. Leaves were surface sterilized individually using sodium hypochlorite (0.5%) as described by Maldonado et al. (2003) after a modification of the method used by Lodge et al., (1996) under aseptic conditions. After surface sterilization the leaves were placed in sterile paper towel to remove excess water and transported to an aseptic area. In the aseptic area each leaf was divided in apex, center, and base. Each segment was transferred to a sterile Petri dish and fragmented in nine sections (approximately 1x1cm). In Petri dishes (100x15mm) containing Marine Agar (MA, 55.1g/L distilled water, Difco) supplemented with chloramphenicol to avoid bacterial growth, sub groups of three sections were placed equidistant from each other. The plates were labeled with the initial of the sampling site and the sampling number (ie, B1 or B2 for the Buyé Beach samplings), the quadrant number (Q1, Q2, or Q3), plant number (P1, P2, P3, P4, or P5), and leaf section (A for apex, C for center, or B for base), sealed with Parafilm, and incubated at 25ºC for 45 days. Daily observations were taken and as soon as growth was observed emerging from the edge of the incubated segments, subcultures were made.
Experimental controls: Our experimental controls consisted of only documenting as endophytes the growth of colonies emerging from the side of the surface sterilized fragments. Also, a total metagenomic extraction was performed to samples of surface sterilized leaf tissue to validate the effectiveness of the surface sterilization process. After the assay, an agarose gel revealed no DNA in the sample (Fig.39). DNA exposed to the sodium hypochlorite (0.5%) treatment was completely degraded, including DNA from epiphytic origin.
We also incubated unexposed Petri dishes containing the agar media used to inoculate the surface sterilized leaf fragments as negative control. Successful controls did not show grow of colonies after incubation. During the processing of the samples inside the microbiological hood we exposed Petri dishes containing the agar media used to inoculate the surface sterilized leaf fragments. Successful controls did not show grow of colonies after incubation.
Recovery and identification of fungal isolates: Mycelial growth emerging from the edge of surface sterilized fragments showing distincitive morphological characteristics was sub-cultured in sterile Petri dishes (60x15mm) containing fresh MA and Potato Dextrose Agar (PDA, 39g/L distilled water, Difco). Colony characteristics were documented from pure culture (colony color and form, texture, elevation, and presence of exudates) after incubation at 25ºC for a period of 7 days or until growth was observed. To promote sporulation, colonies were transferred to different culture media: Oatmeal Agar (OA, 72.5g/L distilled water), Sporulation Agar (SA, as proposed by Jong and Edwards in 1991), Malt Extract Agar (MEA, 33.6g/L distilled water), PDA, and Potato and Sucrose Agar (PSA, as proposed Booth, 1971). Identification of Penicillium spp we used Yeast Extract Agar (YEA), MEA, and 25%Glycerol and Nitrate Agar (G25N) as proposed by
Pitt (1985). To identify species of Aspergillus we used YEA, MEA, and Czapek Yeast Extract Agar with and 20% sucrose (CY20S) as described by Klich and Pitt (1988).
Microscopic characterization of the fungal endophytes in pure culture was achieved by preparing wet mounts with lactophenol cotton blue of the cultures growing in slide cultures (Riddell, 1950). Observations at 40X and 60X were made using a light microscope (Olympus U-CMAD3). Different taxonomic keys were used to identify the various genera and species recovered (Barnett and Hunter, 1986; Sivanesan, 1987; Klich and Pitt, 1988; Pitt, 1985; etc). The fungal cultures identified were documented using a digital camera (Olympus, Camedia C-7070) adapted to a light microscope (Olympus UCMAD3) Figures 8-13. A photographic catalog documenting the diversity of fungal endophytes was prepared (Supplement 1) to easy future identifications. Also, a culture collection in glycerol named Sea Grass Endophytic Culture Collection was prepared and deposited in an ultra-low freezer (-80ºC) located at B-218A.
Extraction of fungal DNA: To corroborate the morphological identification of the fungal endophytes recovered we performed DNA extractions for each isolate. A protocol from Puregene (Appendix 4) for the purification of 0.5-2.0mg of solid tissue was used after various modifications.
To achieve cellular lysis a portion of a fresh fungal colony was placed in a 1.5ml microtubes containing 100µl of the Cellular Lysis Solution. Microtubes were transferred to the ultra-low freezer (-80ºC) for 20 minutes and then transferred to a heating block (65ºC) for 15 minutes. Using a sterile mortar each sample was macerated for 30 seconds. The freezing, heating, and maceration procedures were repeated three times to ensure a good yield of genetic material available for the PCR. After the third cycle of freezing, heating, and maceration 0.7µl of K Proteinase were added to the microtubes followed by agitation and centrifugation for 30 seconds. After centrifugation, the microtubes were incubated with agitation at 55ºC overnight. The next day, the microtubes were removed from the incubator and let to rest at room temperature.
After completing the cellular lysis procedure, the genetic material was cleaned. We started by adding 0.5µl of RNAse solution to each microtube and mixing by inversion of the tubes 25 times. This step was followed by an incubation period of 60 minutes at 37ºC. For protein precipitation, the sample was let to rest at room temperature and 33µl of the Protein Precipitation Solution were added to each microtube containing the RNAse treatment. The sample was homogenized using a Vortex for 20 seconds and cooled in ice for 5 minutes. The microtubes were centrifugated at 13,000-16,000rpm for three minutes o until a pellet was observed.
To clean the genetic material, the supernatant from each sample was decanted into new sterile 1.5ml microtubes. To each microtube, an equal amount of cold isopropanol was added and centifugated at 13,000-16,000rpm for 5 minutes. The supernatant was decanted and the microtube let to dry inverted. Finally, 100µl of cold 70% ethanol were added to the microtubes and mixed by inversion three times to wash the genetic material. The samples were centifugated at 13,000-16,000rpm for one minute, the ethanol decanted, and the microtubes let to dry at room temperature inverted over absorbent paper overnight. The next day, the DNA was re-hydrated by adding 20µl of the DNA
Hydratation Solution to each microtube and incubated at 65ºC overnight. The resulting
DNA material was stored at -20ºC after determining the DNA concentration by running an electrophoresis gel with a 1Kb ladder.
To amplify the region of interest we perform PCR to each sample with the markers ITS1 5’-TCC GTA GGT GAA CCT GCG G-3’ and ITS4 5’-TCC TCC GCT TAT G-3’. Reactions of 12.5µl of Go Taq Green Master Mix, 2.0µl of the ITS-1 primer, 2.0µl of the ITS-4 primer, 2.5µl of the DNA sample, and 6.0µl of water free of nuclease were prepared and run in the PCR machine (MJ Mini Thermal Cycler, Bio Rad) following the Promega protocol (Appendix 1). PCR products were purified with Wizard, SV Gel, and PCR Clean-up Sytem (Promega) as described in and Appendices 2-4 and sent to the sequencing facilities at UPR-M and UPR-RP. The sequences obtained were analyzed and corrected using Codon Code Aligner (version 2.0.4). Comparisons of each particular sequence with sequence banks available such as GeneBank (http://www.ncbi.nlm.nih.gov) were achieved using BLAST. The sequences used are included in Appendix 5.
Salinity tests: Twenty isolates showed a limited growth when transferred to routinely commercial culture media. In order to complete their identification, we transferred these isolates individually to MA supplemented with different concentrations of NaCl (1%, 2.5%, 5%, 10%, and 12.5%). Daily data was recorded to determine their tolerance or requirement of particular NaCl concentrations for their growth and development. Depending of their particular ability to tolerate particular NaCl concentrations we classified them as halotolerant (growing either in absence or presence of NaCl) or halophilic (requires NaCl to grow).
Bioassays to evaluate interactions among foliar endophytes of Thalssia testudinum: Throughout the extent of the research we observed that 51 isolates, pertaining to eight different genera, were exudate-producing fungi. Usually, fungi that produce exudates in culture are good candidates to be evaluated for bioactivity against pathogenic microorganisms. To evaluate the potential of these endophytes as producers of bioactive compounds that can protect the host plant against opportunistic or pathogenic bacteria we design a preliminary an in vitro bioassays with sterile filter discs impregnated with fungal extracts to evaluate the interactions among the endophytic microflora isolated from surface sterilized foliar tissue.
Fungal cultures: To perform the bioassays fresh broth cultures of fungal endophytes from T. testudinum (Aspergillus fumigatus, A. niger, Acremonium strictum, Curvularia lunata, Penicillium miczynskii, P. janthinellum, Paecylomyces variotii, and Trichoderma reesei) were prepared by inoculating each fungi individually in 500ml of Potato Dextrose Broth and incubate in a rotary shaker for 14 days at 25ºC. The incubation period allowed the fungi to growth and produce secondary metabolites during the late-growing phase. After filtration of the incubated broth, sterile filter discs were impregnated with the broth and challenged with fresh bacterial fields of the selected bacterial strains as described below.
Bacterial cultures: For the bioassay, plant pathogenic opportunistic bacterial strains of Burkhoderia cepacia, Erwinia caratovora, E. chrysantemi, Pseudomonas aeruginosa, P.
cichori, Xantromonas anoxopodis pv. translucens, X. campestri pv. campestri, and X. campestri pv. fuscans and twenty-four (24) endophytic bacterial strains isolated from T. testudinum were inoculated individually on Tryptic Soy Agar (TSA) using sterile spreaders to create a homogenous bacterial field. Cultures were incubated for 24 hours at 37ºC. To perform the bioassays both the fungal extracts and the bacterial fields need to be fresh.
Biossays: The bioassays were performed by placing four sterile filter discs impregnated with the fungal extracts over the bacterial field at equidistant position from one another. In every dish we included a control disc, consisting of a filter disc impregnated with sterile water. We incubated the plates for 24 hours at 25ºC and made replicates that were incubated at 37ºC (Fig. 2). Observations were made after the incubation period to evaluate the interactions. The data was documented as inhibition of bacterial growth around the impregnated discs, promotion of bacterial growth (evidence of bacterial growth around the impregnated discs) or no interaction. Fungal isolates that promoted bacterial growth were prepared for observation under the Scanning Electron Microscopy (SEM).
Inoculate exudate producing fungi in broth media

Incubate at 25C in a rotary shaker at 120rpm









Fig. 2. Scheme representing the procedure use to perform the in vitro bioassays.
Isolation and screening of secondary metabolites
Antibacterial screening procedure: For the antibacterial tests, they first cultured Salmonella, Pseudomonas, and two Gram-negative bacterial species, in 20 ml of a liquid media and incubate for 24 hours. After the incubation period 100 µl of each bacteria was inoculated on Milton Hueller’s Agar (MHA) using glass beads to create a bacterial field. The inoculated media was incubated at 37ºC for 24 hours.
To perform the anti-bacterial bioassays, twelve (12) sterile paper discs were cut in half. The cut paper discs were placed on the two plates; therefore, 6 discs were placed directly on the plate with Salmonella and 6 discs directly on the Pseudomonas. Ten (10) µl of concentrated fungal extracts (7-12) on each of the discs that were placed directly on the bacterial fields.
With exudates 1-6 a similar process was followed but because there was not very much sample in any of the tubes the concentrations were adjusted slightly. To tubes 1-6, about 4 drops of 100% ethanol were added to dilute them down and to provide enough sample to test. Due to the ethanol present in the samples, these exudates could not be added directly onto the bacterial fields for the test. Instead, 12 half-discs were placed on a sterilized glass surface. Onto each disc 10 µl of exudate/ethanol sample were added and allowed the ethanol to evaporate. This procedure was repeated for a second time placing 10 µl of each exudate/ethanol sample onto each of the twelve discs. Once the ethanol evaporated a second time from the discs, each impregnated disc was placed onto the MHA culture plates that contained the bacterial fields. The exudate in tube 3 contained a larger volume of sample than the other exudate samples. In order to avoid saturation of the whole paper disc, the exudates were placed directly onto the paper disc using a epindorf with a capillary open at both ends. No ethanol was added to this sample.
Once the Salmonella and Pseudomonas culture plates were inoculated, plates were incubated for about 16 hours at 37ºC so the bacteria could grow. After the 16 hour incubation period, the culture plates were evaluated.
High performance liquid chromatography procedure: To perform these analyses exudates samples were diluted in 100% ethanol (EtOH), enough to make about a 50:50 exudate/EtOH mix. Ten (10) µl of the 50:50 exudate/EtOH mix were drew into a syringe and deposited into the HPLC. The HPLC started with 100% H2O as the solvent, and the HPLC system was set to increase acetonitrile by 10% every 10 minutes. At the 60 min point, the HPLC system increased the acetonitrile concentration to 100% and run for 15 more min, for a total of 75 min. Every 2 minutes fractions were collected to test against the Gram-negative bacterial species. The exact process was repeated a total of three times and each time fractions were collected every two minutes.
After the collection of the individual fractions three times each, an anti-bacterial test on each fraction was performed using the same anti-bacterial protocol explained previously. The fractions which contained acetonitrile were allowed sufficient time to evaporate the acetonitrile before placing the discs saturated with each fraction on the bacterial fields.
Mass spectral analysis: Mass spectra were run on an Agilent LC/MS equipped with a time of Flight (TOF) electrospray mass spectrometer and diode array detector. Initially, the mass spec data of each of the extracts tested showed only junk peaks. The most prominent junk peak consistently appeared at around 354 amu. Additionally, the intensity of the total ion current (TIC) graph was very low. We like to have the intensity show up in the range of 1.0e5 to 9.0e6 cps. The TIC intensity only showed up in the range of 1.8e4 to 2.0e4 cps. This range suggests two things: either the compound of interest is not ionizable in the MS, or the sample was not concentrated enough.
We did further analysis on the MS using a MS analysis computer program. This program allows us to look further at the intensity and the absorbance of the compound. This more detailed analysis allowed us to determine that the compound is ionizable in the mass spec because the absorbance from the Diode Array Detection (DAD) Signal Data shows a prominent peak between about .10 and .25 minutes. This is a good range for absorbance. Also, the absorbance on the DAD graph indicated that we are getting a good absorbance from the UV detector. Furthermore, the TIC graph showed an intensity much higher than previously displayed. It showed an intensity to the power of 5 cps for all of the samples that we tested. These new peaks help us to understand that the compound of interest is ionizable and it is being sufficiently detected in the MS.
Host specificity tests: Environmental chambers: A customized system was assembled in the laboratory (Fig. 3-D) to perform the host specificity tests under controlled environmental conditions. We connected six plastic cylinders (22 x 9.2 cm) each fitted with plastic tubing to provide continuous 02 supplies to avoid the deterioration of the plants. To supply the 02 we attached an aquarium bomb to each cylinder. Two liters of filtrated seawater were placed in each container. Previously, the seawater was let to settle for one month to eliminate the biological components in the water column. Before introducing the plants we run the system for one day to oxygenate the system.
Fig. 3. Undamaged individual plants of T. testidinum used for host specificity tests (A), inoculation procedure (B), indivisual leaves for host specificity tests under non-controlled environmental conditions (C), and customized system assembled to perform host specificity tests under controlled environmental conditions (D).
Inside each cylinder containing the marine water three individual plants of T. testidinum (fig. 3-A) with main roots and developed, undamaged leaves were placed inside each cylinder. To allow the plants to sit at the bottom of the cylinder, we attached a piece of dead coral previously cleaned to the rhizome of the plant using cord. A total of eighteen (18) plants were used in this experiment, including six controls. Two of the plants in each cylinder were labeled as infected and the other was kept as control. The system with the plants was evaluate for fourteen (14) days to determine if the plants survive previously to perform the host specificity tests. Every day, temperature, salt concentration, and water levels were evaluated and corrected if necessary. Alternated cycles of light and darkness using an artificial light (n:vision, 150W) were provided to recreate the natural light cycles to which the plants are exposed (Fig.3-D) .
For host specificity test under uncontrolled environmental conditions three individual undamaged leaves were placed in plastic containers containing 500 ml of the filtered seawater (Fig. 3-C). Two of the leaves were inoculated with the fungal endophyte and one leaf was left uninoculated as a control.
Inoculation of host plants: The inoculation procedure was carried out after the fourteen days of stabilization of the environmental chambers. Pure cultures of six endophytic fungi (Aspergillus flavus, Botrytis cinerea, Acremonium strictum, Cladosporium cladosporoides, Curvularia lunata, and Penicillium janthinellum) were transferred to Potato Carrot Agar for 7 days at 25ºC. After the incubation period, the entire colony was removed from the agar and suspended in 100 ml of sterile water with 3 drops of Tween 20 (Sigma Chemical Co.) and mixed gently (Vélez-Rodriguez, 2001). The concentration of conidium/ml was determined by utilizing a hematocitometer (Hausser Scientific, 3120). Using a sterile needle 100µl of the spore suspension (105 conidia/ml) was inoculated at three different places in each leaf of the two plants (Fig. 3-B). No inoculations were made in the control plant. The system was placed inside a chamber that provided the alternated cycles of light and darkness using an artificial light (n:vision, 150W). Also, temperature, salt concentration, and water levels were measured daily and corrected, if necessary to maintain initial environmental conditions.
For the host specificity test under uncontrolled environmental conditions two of the three individual undamaged leaves were inoculated with the fungal endophyte and one was left as a control. Individual fungal species were inoculated in separated containers to avoid confusing results. A duplicate for each container was inoculated for a final total of four (4) leaves inoculated for each fungal endophyte under evaluation. The containers were enclosed to avoid contamination from environmental sources, such as sedimentation of fungal spores from the air.
To determine the role of the fungal endophytes inoculated, we document any change in the leaf tissue as compared with the control. Damages such as chlorotic symtoms or necrosis, and the loss of vitality of the host indicate pathogenicity of the inoculated fungi. If no change occurs in the tissue, the fungi were considered to have a prophylactic or mutualistic role in the host plant.
Analysis of results
Colonization densities and abundance of fungal endophytes: Colonization density rates (rD%) (number of colonized fragments/6,480), per study area (number of colonized
fragments/810) and per leaf region (number of colonized fragments from each region/number of fragments inoculated per leaf region) were calculated for each sampling. Colonization density rates were compared and to corroborate that rD% were independent of the sampling or the leaf region a X2 test was performed at a confidence level of 95% (Infostat, Professional version 2007). We also calculate the relative frequency of the recuperated genera from each sampling and at each sampling site using Excel (Microsoft, version 9.0).
Endophytic assemblage analysis: One way ANOVA were conducted to determine whether there are significant differences in endophytic diversity among different plant tissues, different sections within plant tissue, and endophytic among different sampling sites. Diversity indices such as Shannon (H’), Simpson (1-D), and Pileu (J) were calculated. The Jaccard similarity index was calculated to compare the endophytic communities between sampling sites.
Recovery and identification of prokaryotic isolates: Figure 4 shows the schematic of the experimental strategy employed for this research. A more detailed explanation of the methods used is below.
Fig. 4. Schematic of the methods used for the determination of the prokaryotic diversity in T. testudinum.
Isolation and characterization of prokaryotic strains: From each surface sterilized leaf section, nine fragments of approximately 1 cm2 were placed in three segment groups. Sterilized tissue was inoculated into Marine Agar (MA) plates for the isolation of marine
prokaryotes (bacteria and possibly archaea). The pH for the medium was adjusted to 7.6 with NaOH 1M. Plates were incubated at 30°C and observations were taken daily for four weeks. Representative strains were transferred periodically and pure cultures were obtained using the four quadrant streak method. The isolates were then inoculated into marine broth for further biochemical and molecular analysis.
Morphological and physiological characterization: Macroscopic characteristics of the colonies were documented using classical microbiological approaches. For microscopic characterization, Gram staining were performed using smears fixed in acetic acid 5% (Dussault, 1955), in addition to spore and flagella stains. Isolated strains were examined for motility in wet mounts using a Nikon microscope with phase contrast capability.
Biochemical tests: All biochemical tests were carried out at 30°C unless it is stated otherwise. Catalase activity will be determined by adding a 1% (w/v) H2O2 solution to colonies on MA. Oxidase test were performed using the Dry Slide (Difco®) biochemical test (Montalvo-Rodríguez et al; 1998). Hydrolysis of starch, Tween 80, and aesculin were determined as described by Cowan and Steele (1965) with the addition of basal salts (5%NaCl, 2% MgSO4 · 7H2O, and 0.2% KCl) to the medium. Hydrolysis of gelatin and production of urease were determined according to Cowan and Steele (1965). Citrate utilization was determined on Simmons citrate medium supplemented with basal salts (Simmons, 1926). Acid production from carbohydrates was determined using phenol red base supplemented with 0.7% of the carbohydrate and basal salts. Motility, H2S production and indole were determined using SIM a multi-test medium comprising 3 tests: sulfide (H2S gas), indole production, and motility supplemented with basal salts. Production of H2S will be determined using the API 20E system as previously described (Yoon et al., 2001). Growth under anaerobic conditions was determined by incubating strains in an anaerobic chamber in MA. Nutritional features will be determined using the Koser medium (1923). The filter-sterilized substrate was added to the medium at a final concentration of 0.1% (w/v), with the exception of carbohydrates, which were used at a final concentration of 0.2% (w/v).
The isolates that were deposited in SGECC were cryo-preserved at -80ºC. The bacterial strains were grown in 1.5 mL microtubes containing 930 µL of Marine Broth. When bacterial culture reached logarithmic phase, 30 µL of Dimethyl Sulfoxide (DMSO) was added. The culture was then flash frozen using -80ºC chiller units and stored in the SGECC freezer.
Molecular characterization of the isolated prokaryotic strains
Genomic DNA isolation and gel electrophoresis: Strains were grown in MA at 30°C. Genomic DNA was extracted according to a modified version of the protocol described by Benlloch et al (2001). The isolated DNA was resuspended in 50 µl of 1X TE (TrisEDTA, pH 8) and treated with RNAse (final concentration of 20 µg/µl) for 30 minutes at 37ºC. The quality of the DNA was checked on 0.8% agarose gels after staining with ethidium bromide. All genomic DNA’s were used as templates for subsequent PCR amplification.
BOX PCR: In BOX PCR DNA fingerprinting, PCR amplification of the DNA between adjacent repetitive extragenic elements is used to obtain strain specific DNA fingerprints which can be easily analyzed by pattern recognition (Dombek et al., 2000). Because of the specificity and resolution of this technique, results will allow discriminating and classifying isolates into groups, reducing the amount of isolates used in further experiments. Isolated strains that have with similar patterns will be clustered into groups and one representative from each group will be submitted to further phylogenetic analysis. BOX PCR was performed using the strains genomic DNA as described previously (Rademaker et al., 1997; Versalovic et al., 1998; Dombek et al., 2000). PCR products were verified on a 3% horizontal low melting agarose gel after staining with ethidium bromide.
PCR amplification and gel electrophoresis: The molecular characterization of isolates with unique genotypes was based on the analysis of conserved regions from the 16S rRNA gene, which was PCR amplified using the bacterial primers 799F and 1492R. The reaction mixture consisted of ddH2O, buffer 1X, MgCl2 2.5mM, dNTP’s 250mM, Primer F 1pmol, Primer R 1pmol, 50ng of template DNA and Taq Polymerase 0.026U/µl. PCR was performed for 30 cycles consisting of denaturation for 1 minute at 94°C, annealing for 1 minute at 50°C and polymerization for 3 min at 72 °C (Hezayen et al., 2002). PCR products were verified in 1% agarose gels after staining with ethidium bromide. PCR products were cleaned by using MinElute PCR purification Kit (USA QIAGEN Inc.) according to manufacturer’s protocol prior to sequencing analysis.
Sequencing and phylogenetic analysis Selected PCR products were sent to the UPR Genomics and Sequencing Facility (Río Piedras, PR.) for sequencing according to the facilities instructions. DNA sequences were used as query in the BLAST program to identify their closest relatives based on sequence similarities. A multiple-sequence alignment was made using the Clustal W program with DNA sequences of closely related organisms (as determined by BLAST analysis). The sequence similarity values were calculated by pairwise comparison of the sequences within the alignment. Distance analysis of sequence similarity was performed using the programs contained in the PHYLIP software package (version 3.5.1). Seqboot program was used to generate 100 bootstrapped data sets. Distance matrices were calculated with DNADIST. One hundred trees were inferred by using the neighbor program. Any bias introduced by the order of sequence addition was minimized by randomizing the input order. The Consensus program was used to construct a tree with the most frequent branching order. The final tree was drawn using TREEVIEW (Felsenstein, 1993; Page, 1996).
Study of the microbial community structure by culture independent methods
a. Leaf Sterilization and processing: The leaf samples were surface sterilized and processed using the protocol described before.
b. Isolation of metagenomic DNA: Total metagenomic DNA extraction was performed using a modified protocol as described by Keb-Llanes et al, (2002). DNA was extracted from the plant tissue with an extraction buffer which consists of 10% SDS, 2% CTAB, 100 mM Tris pH 8.0, 20 mM EDTA, 1.4 M NaCl, 10 mM ß- mercaptoethanol, 0.75 M
sucrose and 5 mg/mL lysozyme. Proteins and salts were precipitated with cold 5 M Potassium acetate, followed by isoamyl: chloroform extraction and isopropanol precipitation. The isolated metagenomic DNA was resuspended in 50 µl of 1X TE (TrisEDTA, pH 8) and treated with RNAse (final concentration of 20 µg/µl) for 30 minutes at 37ºC. The quality of the DNA was checked on 0.8% agarose gels after staining with ethidium bromide.
c. 16S rDNA PCR from metagenomic DNA: Bacterial PCR reactions were performed as described by Chelius and Triplett (2001) using the primers 799 f and 1492 r which would amplify most bacterial sequences while excluding chloroplast DNA. For archaeal 16S rRNA gene amplification, the primers Arch 21 f and Arch 958 r were used. PCR products were verified in 1% agarose gels after staining with ethidium bromide. PCR products were cleaned by using Wizard SV Gel and PCR Cleanup System purification Kit (Promega Inc.) according to manufacturer’s instructions.
Cloning of PCR products and generation of environmental 16SrDNA clone libraries: The PCR products were ligated into pGEM®-T cloning vector, and transformed into JM 109 high efficiency competent cells as described by the manufacturer (Promega). Transformed cells werte plated in Luria-Bertani (LB) agar plates with ampicillin (100 µg/ml). Plasmid extraction from selected clones was performed using the QIAprep Spin Miniprep Kit (USA QIAGEN Inc.) according to manufacturer’s protocol. Plasmids were sent to UPR Genomics and Sequencing Facility (Río Piedras, PR.) for DNA sequencing. Sequences were analyzed and phylogenetic trees were constructed as described above.
Whole prokaryotic community fingerprints
Terminal Restriction Fragment Length Polymorphism(T-RFLP): The T-RFLP technique was used to establish differences and similarities among the structure of microbial communities between samples. This culture independent technique creates community profiles and patterns for each sample by fingerprinting than can be compared for further analysis. Total DNA 16s rDNA will be amplified using the labeled primer pair 27 F/ FAM and 1392R. TRFLP fingerprinting was applied using three different restriction enzymes: RSA I, HAE III and HhA I and the community TRFLP patterns will be analyzed in a gel based sequencer (Licor).
RESULTS AND FINDINGS
A. Fungal endophytes
During the extent of this research we processed a total of 6,480 leaf fragments from 120 individual plants of Thalassia testudinum Bank ex K.D. Koenig and 54 leaf fragments from two plants of Syringodium filiforme Kuetz. A total of 724 leaf fragments of T. testudinum were colonized with endophytic fungi, whereas 14 leaf fragments from S. filiforme were colonized, representing a total colonization density of 11.0% and 26.0%, respectively. A x2 test revealed that colonization densities (rD%) are not related to the sampling season, but ANOVA revealed that rD%’s are related to the sampling site (p=0.01).
Our results documented distinctive assemblages of fungal endophytes from T. testudinum in all four study areas. Table 1 summarizes rD% calculated per sampling site
and per sampling. Our data show that seagrass beds of T.testidinum sampled at Buyé Beach have the highest colonization density rate (21%) in average when compared to Los Morillos (14.4%), Cayo Enrique (13.4%), and Puerto de la Libertad (3.45%). Table 1 also summarizes rD%’s calculated per leaf region at each sampling site. ANOVA suggested that fungal endophytes from T. testudinum have no preference for any particular leaf region.
Table 1. Relative density of colonization (rD%) of foliar endophytes of Thalassia testudinum at Buyé Beach, CayoEnrique, Puerto de la Libertad, and Los Morillos isolated by sampling period and partitioned in apex, center, and base.
Endophytic fungal communities inhabiting the internal foliar tissue of sea grass beds of T. testudinum were rich in diversity. We isolated and purified 749 colonies of fungal endophytes from surface-sterilized leaf fragments of T. testudinum. A total of 38 fungal taxa, 4 morphotypes, and 27 unknown fungi denominated MWRS (mycelia without any reproductive structures were isolated from a total of 6,480 surface sterilized leaf fragments. All identifications were corroborated by genetic analysis of two ITS regions. We recuperated species of twenty-one different genera, including Aspergillus (0.375), Penicillium (0.142), Cladosporium (0.143), and Curvularia (0.044). We also identified Alternaria tenuissima (0.001), Bipolaris sorokiniana (0.009), Blastomyces dermatitidis (0.009), Botrytis (0.009), Acremonium (0.012), Phoma (0.008), Colletotrichum (0.003), Fusarium (0.021), Nigrospora sp (0.013), Glyocephalis hyalina (0.059), Geotrichum (0.013), Helicosporium (0.036), Oidium (0.004), Paecilomyces
variotii (0.013), Pestalotia (0.013), Scolecobasidium constrictum (0.012), Trichoderma reiseii (0.016), and T. spirale (0.036). Isolates of a pathogenic oomycete, Phytophthora sp (0.013) were also recovered. Figures 5-8 summarize the relative frequencies of recuperated species per genera and per sampling site.
MWRS
Trichoderma spirale
Trichoderma reesei
Scolecobasidium constrictum
Pestalotia sp.
Phytophthora sp.
Penicillium miczynskii
Penicillium janthinellum
Penicillium variabile
Isolated genera
Penicillium citrinum
Paecilomyces variotii
Oidium sp.
Nigrospora sp.
Levaduras
Hortaea werneckii
Helicosporium sp.
Geotrichum sp.
Gliocephalis hyalina
Fusarium sp.
Relative frequency
Fig. 5. Relative frequency of species of foliar endophytic fungi from T. testudinum.
Isolated genera
Colletotrichum sp.
Curvularia pallescens
Curvulara brachyspora
Curvularia lunata
Phoma sp.
Acremonium sp.
Cladosprium herbarum
Cladosporium cladosporoides
Cladosporium oxysporum
Cladosporium sphaerospermum
Bipolaris sorokiniana Botrytis sp.
Blastomyces dermatitidis
Aspergillus niger
Aspergillus versicolor
Aspergillus fumigatus
Aspergillus sydowii
Aspergillus ustus
Alternaria tenuissima
00.050.10.150.20.250.3
Relative frequency
6. Relative frequency of species of foliar endophytic fungi from T. testudinum (cont.).
Isolated genera
Colletotrichum sp.
Curvularia pallescens
Curvulara brachyspora
Curvularia lunata
Phoma sp.
Acremonium sp.
Cladosprium herbarum
Cladosporium cladosporoides
Cladosporium oxysporum
Cladosporium sphaerospermum
Botrytis sp.
Bipolaris sorokiniana
Blastomycesdermatitidis
Aspergillus niger
Aspergillus versicolor
Aspergillus fumigatus
Aspergillus sydowii
Aspergillus ustus
Alternaria tenuissima
00.20.40.60.811.21.4
Relative frequency
Buyé Beach
Buyé Beach2
Cayo Enrique CayoEnrique 2
Puerto de la Libertad
Puerto de laLibertad 2
Los Morillos
LosMorillos 2
Fig. 7. Relative frequency of species of foliar endophytic fungi from T. testudinum per study area.
Isolated genera
MCER
Trichoderma spirale
Trichoderma reesei
Scolecobasidium constrictum
Pestalotia sp.
Phytophthora sp.
Penicillium miczynskii
Penicillium janthinellum
Penicillium variabile
Penicillium citrinum
Paecilomyces variotii
Oidium sp.
Nigrospora sp.
Levaduras
Hortaea werneckii
Helicosporium sp.
Geotrichum sp.
Gliocephalis hyalina
Fusarium sp.
Buyé Beach
Buyé Beach2
CayoEnrique
CayoEnrique 2
Puerto de la Libertad
Puerto de laLibertad 2
Los Morillos
LosMorillos 2
Relative frequency
Fig. 8. Relative frequency of species of foliar endophytic fungi from T. testudinum per study area (cont.).
Figures 9-14 contains photographs of the most commonly isolated fungal species. From S. filiforme we isolated A. fumigatus, Cladosporium cladosporioides, and T. reseei.

Of crucial interest are isolates reported here for the first time as endophytes of T. testudinum and other that can be providing the host with important ecological advantages, previously reported for terrestrial plants. Gliocephalis hyalina (Fig. 12 G-H) and Blastomyces dermatitidis are reported here for the first time as fungal endophyte and as endophyte of T.testudinum, respectively. These fungi are rarely isolated from terrestrial environments and were recovered in high frequency from Los Morillos. For identification, they required cultivation in Marine Agar at NaCl concentrations higher than 2.5%, demonstrating their halophilic nature. This characteristic could be used as criteria to select these fungi to implement restoration efforts in vivo. Another good candidate with similar characteristics are isolates of Cladosporium cladosporoides that also grew at NaCl concentrations higher than 2.5%. Halophilic fungi could be providing a homeostatic mechanism to regulate the internal environmental of the host, thus providing an additional ecological advantage to tolerate salt stress.
Alternaria tenuissima, Aspergillus sydowii, A. versicolor, Bipolaris sorokiniana, Cladosporium herbarum, C. sphaerospermum, Pestalotia sp, Paecylomyces variotti, Trichoderma reesei, and T. spirale are reported here for the first time as fungal endophytes of Thalassia testudinum. In more detail, isolates belonging to Acremonium sp. has been reported previously from the marine environment, protecting colonized tissue of their host sponges, by inhibiting the growth of other microorganisms and producing secondary metabolites (Holler et al., 2000). Reports from terrestrial host indicated that Acremonium spp (Fig. 9 A-B) could be disseminated through seeds. Because Acremonium spp are well know for their capacity to produce various secondary metabolites is terrestrial substrates, including some with antibiotic activity this characteristic could be used to improve restoration efforts in impacted seagrass beds. Similarly, Penicillium spp (Fig. 13 A-F) has the same characteristics as Acremonium strictum, making them good candidates for further research as restoration tools.
Species of Aspergillus (Fig. 10) has been isolated previously from the marine environment as well as endophytes of Thalassia testudinum (Maldonado et al, 2003; Malavé, 2006). These species are ecologically important because can be either acting as beneficial fungi or as pathogens. For example, we isolated Aspergillus fumigatus (Fig. 10 A-B), a species known by its ability to produce a wide array of secondary metabolites that can be beneficial or detrimental for both humans and animals. A. niger (Fig. 10 C-D) is well know to cause opportunistic mycoses in humans, but is an important component of the global carbon cycle. A. ustus was reported by Lucero (2007) to confer salt tolerance to plants in in vitro bioassays. Plants inoculated with the fungi were reported to have higher survival frequencies. This species could be another candidate for improvement of restoration efforts. Lastly, Aspergillus sydowii (Fig. 10 G-H) a fungus known as the causal agent for the coral bleaching of Gorgonia sp in the Caribbean (Alker et al. 2001) was recuperated from three different sampling sites. Although in lower frequencies, it could be interesting to study the relation between the colonization density in T. testudinum and the disease levels in adjacent coral populations when both hosts occurred together.
We report here the occurrence of Alternaria tenuissima (Fig. 9 C-D), Botrytis sp, Bipolaris sorokiniana (Fig. 9 E-F), Colletotrichum sp (Fig 12 I-J), and Phytophthora sp (Fig. 14 A-B), organisms known to be pathogenic to various terrestrial plant species. Interestingly, none of these species were recovered in high frequencies, maybe due to the
fact that they were co-existing with other fungi, known as producers of potent mycotoxins and antibiotics such as Penicillium, Aspergillus, Curvularia, and Acremonium. Other species, such as Curvularia lunata (Fig. 12 E-F), reported previously by Ravindran and Raghukumar, (2001) as part of the normal internal flora of corals, could be limiting the colonization by pathogenic/opportunistic species. Curvularia (Fig. 12) species are know for their potential to produce diverse types of mycotoxins and pigments that could act as inhibitory agents for other microorganisms.
Close attention should be paid to the apparent dual nature of Colletotrichum species (Fig. 9 I-J) in the marine environment. Recently, Colletotrichum acutatum was reported as pathogen of Lepidochelys kempi, an endangered marine turtle in the Caribbean (Manire et al, 2002), but also Colletotrichum gloeosporioides was reported as endophyte in Taxus mairei (Wang, et al., 2008), a tree species known as a reservoir for fungal endophytes that produce important anticancer agents, such as taxol. Finally, is important to recognize the potential benefits that isolates of Trichoderma reesei (Fig. 11 C-D) and T. spirale could be providing to the host plants. Athman (2006) reported that both species has been found in beneficial associations with the host’s roots. Also, for many years integrated pest management efforts on terrestrial plants has used Trichoderma viride as a soil treatment to control various fungal pathogens.
In terms of the diversity analyses Cayo Enrique (n=25) showed the highest diversity (H’ and 1-D) and evenness (J) (Table 2). Although Buyé Beach was richer in the number of species this site has the lower evenness index showing the effect of the two dominating species, Aspergillus fumigatus and Penicillium janthinellum.
Table 2. Measures of diversity of the endophytic foliar communities of T. testudinum at Buyé Beach, Cayo Enrique, Puerto de la Libertad, and Los Morillos
The Jaccard index compares the species compositions between sampling sites. It shows how similar sites are by comparing shared species in pairs of habitats. The index ranged from 0 to 1, whereas, high values indicated high similarity. Jaccard index showed higher similarity between Los Morrillos and Buyé Beach (Table 3) whereas Cayo Enrique have more similarity to Puerto de la Libertad than any other site. Comparison between the two sampling seasons (dry and wet) showed less similarity overall than between sampling sites (Tables 3 and 4), but the ANOVA between sampling seasons did not showed any significant differences.
Table 3. Comparison between locations by Jaccard similarity index calculated for foliar endophytic fungal communities isolated from T. testudinum.
Buyé Beach Cayo Enrique Puerto de la Libertad Los Morrillos
Table 4 reflects the tendency that a seasonal change could be occurring in the composition of the endophytic fungal community inhabiting internal foliar tissue of T. testudinum. Three of the four sites sampled showed the lowest similarity when compared to all the values even within different sites (Table 4). When looking directly to the species assemblages recovered from the first sampling (0.059) at Puerto de la Libertad, they are practically different from the species assemblages recovered from the second sampling at the same site.
Table 4. Comparison between seasons (dry vs wet) of Jaccard similarity index calculated for the foliar endophytic fungal communities isolated from T. testudinum.
By looking directly to the assamblage of the endophytic fungal species isolated from the four sampling sites, we found that some species occurred only in a particular sampling site, whereas four species are common among all sampling sites (Fig. 15). This will be discuss later in the context of it relevance for restoration efforts.
Colletotrichum sp.
Alternaria tenuissima
Cladosprium herbarum
Curvularia pallescens
Penicillium variabile
Phytohptora sp.
Pestalotia sp.
Aspergillus ustus
Cladosporium cladosporoides
Curvularia lunata
Penicillium janthinellum
Curvulara brachyspora
Paecilomyces variotii
Trichoderma spirale
Botrytis sp.
Geotrichum sp.
Fig. 15. Distribution of shared endophytic fungal species among sampling sites (inner circle). The blue oval includes Buyé Beach’s unique isolates, the black oval Cayo Enrique’s isolates, the green oval Los Morillos’ isolates, and the red oval Puerto de la Libertad’s isolates.
Salinity tests: The four fungal endophytes evaluated, Cladosporium sp., Cladosporium sphaerospermum, Blastomyces dermatitidis, and Gliocephalis hyalina showed tolerance to NaCl up to 12.5% in both Marine Agar and Malt Extract Ager supplemented with the salt. The ability to tolerate these salt concentrations suggested a halotolerant nature of these fungal endophytes, specially C. sphaerospermum. C. sphaerospermum has been considered extremly halotolerant becuase it has been reported from a wide variety of habitats, including some with osmotic stress (25% NaCl) or without osmotic stress (0% NaCl).
Bioassays to evaluate interactions among foliar endophytes of Thalassia testudinum: Preliminary bioassays indicated that all the tested fungal endophytes are interacting with the bacterial strains evaluated (Fig. 16). Inhibition zones around challenged cultures of Pseudomonas aeruginosa suggested a prophylactic role of Aspergillus niger, Penicillium miczynskii, and Trichoderma reesei. Other fungal isolates such as Acremonium strictum and Curvularia lunata, known for the production of bioactive compounds, promoted the growth of most of the endophytic bacterial strains tested. This data suggest that these
bacterial strains are adapted to co-exist with the endophytic fungi inside the host tissue. When looking at the SEM’s, it showed a structure similar to biofilms formed by the endophytic bacterial strains when interacting in vitro with Aspergillus fumigatus (Fig. 17), Penicillium janthinellum, Paecilomyces variotii, and Trichoderma reesei individually.





Fig. 16. Promotion (A) and inhibition (B) of bacterial growth on in vitro bioassays.



Fig. 17. Conidiophores of Aspergillus fumigatus (A-B) and endophityc bacterial strain growing on sterile filter as observed by SEM (C).
Figures 18 and 19 presented the total frequencies of inhibition/promotion of the bacterial isolates tested. Tables 5 and 6 summarize the results for the bioassays.
Penicillium miczynski
Trichodermareesei
Paecilomyces variotii
Penicillium janthinellum
Curvularia lunata
Acremonium strictum
Aspergillus niger
Aspergillus fumigatus
Fig. 18. Frequency of interactions among endophytic fungi from T. testudinum and plant pathogenic opportunistic bacterial strains.
Penicillium miczynski
Trichoderma reesei
Paecilomyces variotii
Penicillium janthinellum
Curvularia lunata
Acremonium strictum
Aspergillus niger
Aspergillusfumigatus
Frecuencyof interaction Inhibition Promotion Nointeraction 00.20.40.60.811.2
Frecuencyof interaction
Inhibition Promotion Nogrowth
Fig. 19. Frequency of interactions among endophytic fungi and endophytic bacterial strains isolated from T. testudinum.
Table 5. Interactions among microbial endophytes from surface sterilized foliar tissue of Thalassia testudinum.
Endophytic
Fungal endophytes
X indicates promotion of the bacterial growth, O indicates fungal growth, - indicates no interaction observed between the endophytes, + indicates overgrowth.
Table 6. Interactions among fungal endophytes from surface sterilized foliar tissue of Thalassia testudinum and plant pathogenic opportunistic bacteria.
Plant pathogenic opportunistic bacterial
Pseudomonas aeruginosa
Xanthomonas campestris pv campestris
Xanthomonas axonopodis pv axonopodis
Xanthomonas axonopodis pv translucens
Xanthomonas campestris pv phaseoli
Burkholderia cepacia
Erwinia caratovora
Erwinia chrysantemi
Pseudomonas cichorii
Xanthomonas campestris pv phaseoli var. fuscans
Fungal
endophytes
X indicates promotion of the bacterial growth, O indicates fungal growth, - indicates no interaction observed between the endophytes, + indicates overgrowth.
Isolation and screening of secondary metabolites
Antibacterial screening procedure: After the 16 hour incubation period, none of the 12 discs showed any inhibition zone, therefore, we were able to conclude that none of the samples showed activity against the bacteria tested (Gram-negative bacteria species, Salmonella spp. or Pseudomonas spp.).
HPLC: Since the anti-bacterial tests were negative on all of the exudates and extracts, they only analyzed exudates 4 and 6, to see if some information could be obtained despite the negative anti-bacterial tests. They found that exudate 4 has an absorbance of 750 microvolts and produced two peaks, but showed no activity against the Gram-negative bacterial species tested. For exudates 6 they found no absorbance region neither peaks, and concluded that it was only noise.
The printouts of the UV detection for exudate 4 indicated that there were two peaks that were tall and pronounced at a time of about 38 minutes and 45 minutes. We expected the fractions that I collected at these times to be active against bacteria, but they were not. Indeed, the two peaks are tall and pronounced, but they only have an intensity of about 750 microvolts. This lack of intensity in the peaks suggests that the concentration of the compounds that correspond to these peaks is not great enough to show activity against the bacteria.
MS analysis: Since we know the compound of interest has been detected in the MS, we needed to delete the junk peaks. We figured that the junk and solvent peaks were relatively much stronger than our peaks of interest and were covering up the peaks of interest. Once we deleted the junk and solvent peaks, we were able to detect two interesting peaks, consistently showed up at around 675 amu and at 837 amu. We believe that either both or one of these peaks could possibly be the compound produced by your fungus that is killing the bacteria. Unfortunately, as indicated by the TIC intensity and by the relatively taller junk and solvent peaks, the compounds that could be responsible for the antibacterial activity appear to be present in relatively insignificant concentrations in the samples that we received. As we have already explained, we have been unable to perform an anti-bacterial assay that would verify whether or not these mass spec peaks are active against bacteria. MS analysis was performed on extracts 7, 8, 9, 11, 12. Extract number 10 was excluded because it had become contaminated with some sort of bacterial growth. Table 7 summarizes the results.
Samples:PossibleMassesofInterest
Host specificity tests: Aspergillus flavus, Botrytis cinerea, Acremonium strictum, Cladosporium cladosporoides, Curvularia lunata, and Penicillium janthinellum were tested in vitro in two different host specificity tests. After an incubation period of fourteen (14) days none of the fungi evaluated caused damage in the infected foliar tissue of T. testudinum maintained under controlled environmental conditions (Fig. 20 A-B). Based on host specificity tests we concluded that the inoculated fungi have a mutualistic/prophylactic relationship with T. testudinum. This was the first attempt to study the interaction between the endophytic fungi and Thalassia testudinum using in vitro host specificity tests.
Individual infected leaves under non-controlled environmental conditions showed multiple lesions (foliar stains, chlorotic lesions, and necrosis) (Fig. 20 C). The necrosis appeared from the apex to the base and the chlorosis was almost in the center of all the leaves. Some of the lesions were similar to the ones observed in leaves at the sampling sites. Interestingly, none of the fungi inoculated were recovered from test tissue, suggesting that endophytic fungi inoculated are not virulent. The damaged in the tissue of the individual leaves could be caused by the stress in which the leaves were kept (the temperature constantly varies between 23˚C and 26˚C) or because they were lacking their root system.
Fig. 20. Inoculated leaves from container under controlled environmental conditions (A-B) and inoculated leaves kept under non-regulated enviromental conditions (C) after 2 weeks of incubation.
B. Prokaryotic endophytes
I. Evaluation of the endophytic prokaryotic diversity by culture-dependent techniques.
a. Strain isolation and morphotype diversity: Endophytic colonies were visible in MA plates at 30°C after 24 hours of incubation (Figs. 22, 25, 28, and 30). Colonies were selected and transferred to MA plates until pure cultures were achieved. A total of 1,274 isolates were obtained from all the sampling sites. The distribution of isolates per sampling site was: Buyé Beach 522, Cayo Enrique 269, Puerto de la Libertad 287, Los Morillos 196. Figure 21 shows the distribution of isolated strains in percentage per sampling site.
Buyé Beach
Cayo Enrique
Puerto de la Libertad
Fig. 21. Distribution of total prokaryotic endophytes isolated per sampling site.

Fig. 23. Colonies from endophytic strains isolated on MA from healthy tissue of T. testudinum from Buyé Beach: Strain B277B (A), Strain B162 (B), Strain B120 (C), and Strain B275B (D).

from
isolated
Fig. 27. Colonies from endophytic strains isolated on MA from healthy tissue of T. testudinum from Puerto de La Libertad: Strain VQ203 (A), Strain VQ208 (B), Strain VQ237 (C), and Strain VQ25 (D).

Fig. 31. Colonies from endophytic strains isolated on MA from healthy tissue of T. testudinum from Los Morillos. Four quadrant streak plates for purification of strains (A, B), Strain S209 (C), and Strain S91 (D).

Morphologically, colonies isolated from Puerto de la Libertad exhibited more diversity, followed by the ones from Buyé beach. Colonies from Cayo Enrique and Los Morillos showed the least diversity of morphotypes, having a common strain which predominates between the isolates. This shared morphotype is a rhizoid white colony with a very aggressive growth (Figs. 28 and 30). Examples of colony morphology and diversity from the different sample sites are shown on Figures 23-24, 26-27, 29, 31-32.
Microscopically, the rod-shaped cells were the most abundant form (76%) followed cocci-shaped cells (24%) among all sampled sites (Fig. 33). Gram staining revealed that 65% of the isolated rod-shaped cells were Gram-positive while 11% were Gram-negative. All cocci-shaped cells were Gram-positive. Previous endophytic microbial diversity studies have shown that Gram-positive rods predominate in this type of environment (Garbeva et al., 2001; Vega et al., 2005). A more detailed distribution based on microscopic characteristics of the isolated strain per sampling site is shown on Fig. 33. It is interesting to point out that the amount of Gram-positive and Gram-negative rods was similar among all the sampling sites. This similarity might indicate that the “basal” endophytic prokaryotic community in Thalassia testudinum is composed of these types of rod-shaped cells. The amount of Gram-positive cocci varied among the sites being the lowest on Puerto de la Libertad and the highest in Buyé Beach (Fig. 34).
Fig. 33. Distribution of the total isolated strains from all sampling sites based on microscopical characteristics. The y-axis denotes number of isolates.
Fig. 34. Distribution of isolated strains among the sampling sites based on microscopical characteristics. The y-axis denotes number of isolates.
b. Molecular and physiological analysis of isolates: After macroscopical and microscopical observations, the isolated strains were further analyzed using molecular approaches. Genomic DNA from all strains was extracted using the phenol/chloroform technique as described in the methods section. Figures 34 and 35 are examples of genomic DNA extractions from isolated endophytes in Thalassia. Due to the high diversity of isolates obtained, a preliminary screening was performed using the BOXPCR technique. In this fingerprinting method, PCR amplification of the DNA between adjacent repetitive extragenic elements is used to obtain strain specific DNA fragments which can be easily analyzed by pattern recognition (Dombek et al., 2000). Because of the specificity and resolution of this technique, results will allow discriminating and classifying isolates into groups, reducing the amount of isolates used in further experiments. Since this technique has not been extensively employed on endophytic microorganisms, several optimizations attempts were performed to achieve optimal result. Figures 37 and 38 show some of the different genotypes obtained using this technique on Puerto la Libertad isolates (sample site with the most diversity of morphotypes). Genotypic Box-PCR fingerprints corroborated the high diversity obtained by morphology (Figures 37 and 38). So far, 67% of the analyzed strains showed unique genotypes which are an indication of a very high prokaryotic diversity inhabiting this environment. We are currently generating fingerprint patterns from the other three sampling sites.



Fig. 35. Genomic DNA extraction of endophytic prokaryotes from Puerto de la Libertad verified in a 0.8% agarose gel stained with ethidium bromide.









Fig. 37. BOX PCR DNA fingerprints from isolates from Puerto de la Libertad verified in a 3% agarose gel stained with ethidium bromide. White arrows (strains VQ19 and VQ37) demonstrate strains with same fingerprints indicating that they belong to the same genotypic group. Red arrow (strains VQ68 and VQ114) show examples of different fingerprints from strains VQ19 and VQ37.






Fig. 38. BOX PCR DNA fingerprints from isolates from Puerto de la Libertad verified in a 3% agarose gel stained with ethidium bromide. No similar fingerprints were found among the analyzed strains therefore, they are considered to belong to different genotypic groups.
Some of the strains that showed unique genotypes were selected for further molecular characterization using the 16S rDNA region. Genomic DNA’s were used as templates for 16S rDNA amplification by PCR. The PCR amplicons obtained had a size of approximately 873bp. It was necessary to perform optimization of the PCR parameters for some strains in order to achieve optimal amplification. Selected PCR products were sent to the UPR Genomics facility for DNA sequencing. Consensus sequences were used as query to obtain closely related microorganisms using the BLAST (www.ncbi.nlm.nih.gov) and the EZ Taxon (Chun et al., 2007; http://147.47.212.35:8080/) softwares. Table 6 shows the closest relative for each strain based on approximately 700bp from the 16S rRNA gene sequence from all sampling sites.
In general, the preliminary results shown here indicate that the Gram-positive bacteria belonging to the phylums Firmicutes and Actinobacteria were among the endophytic strains present in Thalassia testudinum. The Firmicutes was represented by the genera: Bacillus, Halobacillus, Geobacillus, Staphylococcus and Exiguobacterium
The Actinobacteria representatives were Nesterenkonia, Rhodococcus and Micrococcus (Table 8). All the Gram-negative bacteria characterized at the moment of writing belonged to the subdivision Gammaproteobacteria from the phylum Proteobacteria. The representative genera were Microbulbifer, Pseudomonas, Pseudoalteromonas, Vibrio and Chromohalobacter (Table 8). The phylogenetical positions of these isolates and their closest relatives are shown on Figures 18-25. Most of these genera have been reported in the past as normal members of the endophytic communities in terrestrial plants (Gaberva et al., 2001; Vega et al., 2005; Rasche et al., 2006; Thomas et al., 2007). However, we have isolated several genera which have never been reported as inhabitants of plant tissue. Microbulbifer is a genus that has been associated to sea sediments and to mucus and tissues of Oculina patagonica (Koren and Rosenberg, 2008) but there are no records of the presence of this genus on seagrasses. Its presence was recorded on all the sampling sites suggesting that this strain might be a common member of the endophytic community in Thalassia testudinium.
Other marine or halotolerant bacteria like Halobacillus, Pseudoalteromonas, Chromohalobacter and Exiguobacterium have not been reported as endophytes before also. Their presence on Thalassia testudinum suggests the ability of these microorganisms to colonize the host tissue. There are reports that show the epiphytic association of Halobacillus and Nesterenkonia to mangrove leaves (Soto-Ramírez et al., 2007) and stems of Phragmites australis (Kusznyak et al., 2007) respectively. Also, Exiguobacterium has the ability to degrade phenanthrene (Edlund and Jansson, 2008), a contaminant that can be present on marine environments due to anthropogenic impact. Cocci-shaped microorganisms like Micrococcus, Rhodoccocus, and Staphylococcus have been reported as endophytes before on sweet pepper, coffee, sugar cane, and carrot (Rasche et al., 2006; Vega et al., 2005; Velazquez et al., 2008; Surette et al., 2003) but this is the first time they are reported as endophytes on plants from marine environments. One interesting finding was the strain belonging to Geobacillus (L8) isolated from Buyé Beach. There are no reports about the presence of the genus Geobacillus as an endophyte. In fact, members of this genus are characterized for being extremophiles having optimal growth above 50ºC. Strain L8 grows optimally at 30ºC. The
phylogenetical position of this strain together with some physiological properties suggests that strain L8 might be a novel species for this genus (Figure 45).
The genus Pseudomonas was only isolated from Buyé Beach. Species from this genus has been characterized as endophytes (Vega et al., 2005) and a recent study showed that members of this genus can enhance phytoremediation of herbicides (Germaine et al., 2006) and also is associated to the peruphyton of Phragmites australis (Cav.) (Trin. ex Steudel) from Lake Velencei (Borsodi et al., 2007). Pseudoalteromonas is another Gram-negative rod found as an endophyte. Species of this genus have been shown to produce an array of low and high molecular weight compounds with antimicrobial, anti-fouling, algicidal and various pharmaceutically-relevant activities. Compounds formed include toxic proteins, polyanionic exopolymers, substituted phenolic and pyrolle-containing alkaloids, cyclic peptides and a range of brominesubstituted compounds. Ecologically, Pseudoalteromonas appears significant and to date has been shown to influence biofilm formation in various marine econiches, involved in predator-like interactions within the microbial loop, influence settlement, germination and metamorphosis of various invertebrate and algal species, and may also be adopted by marine flora and fauna as defensive agents (Bowman, 2007).
The genus Bacillus was the most frequent and it could be recovered from all of the four sampling sites. Phylogenetically, some strains are closely related to each other forming its own branch. This result suggests that these isolates have developed genetic characteristics that allow them to inhabit plant tissue. Strain VQ 251 was closely related to the endophytic bacterium Bacillus endophyticus which was isolated from inner tissue of healthy cotton plants (Reva et al., 2002). Representatives for this genus had been reported as common endophytic flora for potato, coffee, sweet pepper, and papaya (Garbeva et al., 2001; Vega et al., 2005; Rasche et al., 2006; Thomas et al., 2007) usually found on high numbers. In fact, some studies have demonstrated the importance of having species from this genus as part of the endophytic microbiota. Kishore and collaborators (2005) showed that the addition of species from Bacillus to groundnut had a maximum increase in plant biomass. Bacillus spp. can also contribute to abiotic stress adaptation in pepper (Szideries et al., 2007) and serve as biocontrol agent against phytopatogenic fungi (Cho et al., 2007). One of the most important studies was conducted by Toro and collaborators (1997) where they show that endophytic Bacillus species can solubilize phosphorous and nitrogen for the plant to use as biomass being an extremely important asset to nutrient supply.
It is important to notice that the genus Bacillus was isolated from all sampling sites, being Puerto de Libertad the site with the highest frequency of isolation (Table 8). Thalassia plants present at this site were the healthiest and tallest when compared to the other sites. This site also has the least amount of anthropogenic impact from the 4 studied during this project. The results presented here strongly suggest that depending on the amount and type of anthropogenic impact there is an alteration on the endophytic prokaryotic diversity in T. testudinum being the genus Bacillus the most affected. Even though initial numbers from Gram-positive microorganisms seem similar between sampling sites (Figure 34), most of these isolates in Puerto de la Libertad belong to Bacillus spp. while the other sampling sites reflected a much higher diversity (Halobacillus, Geobacillus, and Exiguobacterium). It also seems like areas receiving a more direct impact, like the recreational area from Buyé Beach, creates a change in
endophytic composition (mainly a reduction of Bacillus spp.) which allows the proliferation of cocci-shaped cells like Microccocus, Rhodococcus, and Staphylococcus and possibly other microorganisms like phytopathogenic fungi. The decreases of members from Bacillus spp. might also allow the increase of the diversity of other prokaryotes (what was observed in Los Morillos and Cayo Enrique) which can no longer provide the benefits that the species of this genus provide. This then affect the plant nutrient supply, reflected in seagrass beds development. This effect can eventually create problems the general ecology of the area. In summary, our results suggest a possible correlation between T. testudinum health and prokaryotic diversity. To our knowledge this is the first report on such kind of correlation. How bacterial changes are affected and how other microorganisms take over remains to be determined.
Table 8. Characterization of several isolated strains from T. testudinum using 800bp of the 16SrRNA gene.
Strain
B 182b
B288
B415
B 421
L2
L8
L16
L19
L20
L25a
LP 29
S1
S23
S25
S47
S210
VQ7
VQ 25C
VQ33B
VQ37B
VQ51
VQ 65B
VQ71
VQ81
VQ 137
VQ182
VQ 190
VQ 209
VQ251
Sampling site
Closest relative
Buyé Beach Bacillus sp.
Buyé Beach Microbulbifer sp.
Buyé Beach Pseudomonas sp.
Buyé Beach Bacillus sp.
Cayo Enrique Halobacillus sp.
Cayo Enrique Geobacillus sp.
Cayo Enrique Staphylococcus sp.
Cayo Enrique Micrococcus sp.
Cayo Enrique Nesterenkonia sp.
Cayo Enrique Rhodococcus sp.
Cayo Enrique Bacillus sp.
Los Morillos Pseudoalteromonas sp.
Los Morillos Vibrio sp.
Los Morillos Chromohalobacter sp.
Los Morillos Microbulbifer sp.
Los Morillos Bacillus sp.
Puerto de la Libertad Bacillus sp.
Puerto de la Libertad Bacillus sp.
Puerto de la Libertad Bacillus sp.
Puerto de la Libertad Bacillus sp.
Puerto de la Libertad Bacillus sp.
Puerto de la Libertad Microbulbifer sp.
Puerto de la Libertad Exiguobacterium sp.
Puerto de la Libertad Microbulbifer sp.
Puerto de la Libertad
Bacillus sp.
Puerto de la Libertad Bacillus sp.
Puerto de la Libertad Bacillus sp.
Puerto de la Libertad Bacillus sp.
Puerto de la Libertad Bacillus sp.
Fig. 39. Phylogenetic tree showing the evolutionary position of strain S47, VQ81, VQ 65B in the genus Microbulbifer. The tree was constructed with the neighbour- joining algorithm and Marinobacter marinus SW-45T T served as outgroup. Bar represents the number of substitutions at certain nucleotide sites. Significant bootstrap values from 100 resamplings of the dataset have been included at nodes.
Fig. 40. Phylogenetic tree showing the evolutionary position of strain VQ71 in the genus Exiguobacterium. The tree was constructed with the neighbourjoining algorithm and Bacillus subtilis NCDO 1769 T served as outgroup. Bar represents the number of substitutions at certain nucleotide sites. Significant bootstrap values from 100 resamplings of the dataset have been included at nodes.
Fig. 41. Phylogenetic tree showing the evolutionary position of strain L20 in the genus Nesterenkonia. The tree was constructed with the neighbour-joining algorithm and Kytococcus sedentarius DSM 20547 T served as outgroup. Bar represents the number of substitutions at certain nucleotide sites. Significant bootstrap values from 100 resamplings of the dataset have been included at nodes.
Fig. 42. Phylogenetic tree showing the evolutionary position of strain L19 in the genus Micrococcus. The tree was constructed with the neighbour-joining algorithm and Kytococcus sedentarius DSM 20547 T served as outgroup. Bar represents the number of substitutions at certain nucleotide sites. Significant bootstrap values from 100 resamplings of the dataset have been included at nodes.
Fig. 43. Phylogenetic tree showing the evolutionary position of strain L25a in the genus Rhodococcus. The tree was constructed with the neighbour-joining algorithm and Rothia aeria served as outgroup. Bar represents the number of substitutions at certain nucleotide sites. Significant bootstrap values from 100 resamplings of the dataset have been included at nodes.
Fig. 44. Phylogenetic tree showing the evolutionary position of strains VQ51, VQ190, VQ33B, VQ7, VQ37B, VQ182, VQ61, and VQ209 in the genus Bacillus. The tree was constructed with the neighbour-joining algorithm and Paenibacillus polymyxa ATCC 202127 T served as outgroup. Bar represents the number of substitutions at certain nucleotide sites. Significant bootstrap values from 100 resamplings of the dataset have been included at nodes.
Fig. 45. Phylogenetic tree showing the evolutionary position of strain L8 in the genus Geobacillus. The tree was constructed with the neighbour-joining algorithm and Bacillus subtilis served as outgroup. Bar represents the number of substitutions at certain nucleotide sites. Significant bootstrap values from 100 resamplings of the dataset have been included at nodes.
Fig. 46. Phylogenetic tree showing the evolutionary position of strain L6 in the genus Staphylococcus. The tree was constructed with the neighbour-joining algorithm and Staphylococcus caseolyticus served as outgroup. Bar represents the number of substitutions at certain nucleotide sites.
Significant bootstrap values from 100 resamplings of the dataset have been included at nodes.
II. Analysis of endophytic communities by culture independent techniques.
Two strategies were employed to study the endophytic community structure by culture independent techniques. The first approach used was T-RFLP (explained on the methods section) and the second was the generation of 16SrRNA gene environmental clone libraries. Both techniques require the extraction of metagenomic DNA from Thalassia tissue. There are several problems associated to this process. Previous studies have expressed concern that the total metagenomic extraction of plant tissue for cultureindependent analysis carries DNA from epiphytic microorganisms which can alter the results obtained for the DNA analysis. In order to address this issue, a reconstruction experiment was designed to demonstrate the efficacy of the surface sterilization technique using sodium hypochlorite. As Fig. 47 shows, a considerable amount of genomic DNA from an isolated strain was submitted to treatment with the sodium hypochlorite solution used for leaf surface sterilization and it was completely degraded (lanes 2 and 5). This is the first time that experimental evidence shows that sodium hypochlorite (0.5%) can degrade epiphytic DNA in addition to sterilize surfaces and therefore validate the protocol for endophytic metagenomic DNA extraction. Figure 48 demonstrate an example of total metagenomic extraction from several samples.
Fig. 47. Validation of effectiveness of the surface sterilization process of leaf tissue of Thalassia testudinum with sodium hypochlorite solution (0.5%). Genomic DNA of strain B 415 (1), genomic DNA of strain B 415 treated with sodium hypochlorite solution (2), genomic DNA of strain B 415 treated with DNA Away Solution (3), genomic DNA of strain S 210 (4), genomic DNA of strain S 210 treated with sodium hypochlorite solution (5), genomic DNA of strain S 210 treated with DNA away solution (6).
Terminal Restriction Analysis was performed on samples obtained from all sampling sites. Metagenomic DNA’s were used as templates for PCR reactions that amplified the almost complete 16S rRNA gene from prokaryotic microorganisms. PCR amplicons were used for enzymatic digestions and the resulting Terminal Restriction Fragments (TRF’s) were loaded to a polyacrylamide sequencing gel using a LICOR sequencer. Figure 40 shows the TRF’s patterns from all the sampling sites and it shows that there are bands shared on all the samples when several restriction enzymes are used. This shared TRF’s probably represent the “basal” prokaryotic endophytic community of T. testudinum. There are specific TRF’s which represent unique members of this community that are present in some samples and are not shared by other seagrass beds. We are currently characterizing these bands to determine to what genus/genera they belong to. However, this technique allowed to compare prokaryotic community profiles between samples and provided important information about similarities and differences among Thalassia prairies in Puerto Rico. Unfortunately, due to optimization and the time-consuming of the technique only preliminary results are presented at the time of writing.
The other problem found at the moment of generating environmental clone libraries from endophytic metagenomic DNA is that the bacterial primers routinely used to amplify the 16S rRNA gene can amplify mitochondrial and chloroplast DNA from Thalassia. To overcome this problem, we selected a set of primers that were specific for bacteria and produce a band of 693bp (Sun et al., 2008). Figures 38 and 50 demonstrate examples of PCR amplification using this set of primers. Several optimizations were performed to achieve optimal amplification of the desire products. Amplicons of correct size were excised from the gel and cloned into pGEM according to the manufacturer instructions. A total of 1,677 clones were obtained using this procedure. The distribution of clones is shown on Table 9. Several clones were selected for sequencing. Sequences similarities to other microorganisms were determined using BLAST software. Table 10 and Figure 51 show the affiliation of several of the obtained sequences. We are currently working on completing this stage of the project. The preliminary data shown here is not enough to make strong conclusions but some points can be made. Some of the clone sequences belong to the genus Bacillus which corroborates the data obtained by culture dependent studies and confirm that this genus is indeed part of the endophytic flora of T. testudinum. Also there are clones representatives of the genera Geobacillus and Microbulbifer which they also were isolated from this environment. Finally, we found evidence for the presence of halophilic archaea as member of the endophytic community. The role of archaea as endophytes is totally unknown and might play more important roles than expected on this type of environment.
Table 9. Distribution of clones from the endophytic genomic libraries from T. testudinum.
Genomic clone

Fig. 48. Metagenomic DNA extraction from surface sterilized T. testudinum leaf tissue from Buyé Beach, Cayo Enrique, and Puerto de la Libertad. Arrows indicate high molecular weight DNA corresponding to total metagenomic endophytic DNA.


Fig. 49. TRFLP of the 16s rDNA gene from the total endophytic prokaryotic community from T. testudinum. PCR reactions were performed with labeled bacteriar primer 27 F: Restriction enzymes for digestion were ALU 1, MSP1 and a double digestion with HhA1 and HAE III. White ovals outlines the shared bacterial populations among all sampled sites. Arrows indicate unique bands representing specific bacterial populations from a specific sea grass bed.


Fig. 50. 16s rDNA gene amplification of metagenomic DNA using 799F and 1492R bacterial primer pair: Lane 1; negative control; L1, metagenomic DNA from Cayo Enrique (first sampling); L2, metagenomic DNA from Cayo Enrique (second sampling).



Fig. 42. 16s rDNA gene amplification of metagenomic DNA using 799F and 1492R bacterial primer pair: B1, metagenomic DNA from Buyé Beach.
Table 10. Affiliations of the 16S rRNA gene sequences obtained from clones of endophytic prokaryotes isolated from foliar tissue of Thalassia testudinum.
Closest relative by 16S rRNA sequence similarity
Sequence representative of OTU’s Taxon Accession number % similary
Beta-Proteobacteria
V 146
V 23
V 122
Alpha-Proteobacteria
V154
Firmicutes
V 25
V 30
V 148
V 152
V 22
V 130
V 142
V 150
V 157
V23
GammaProteobacteria
V 141
V 138
Haloarchaea
L44
Achromobacter insolitus AM113854 100
Janthinobacterium sp. AJ551147 87
Uncultured BetaProteobacterium AB294945 97
Uncultured Afipia sp. EF371496 98
Geobacillus toebii AB116120 98
Bacillus flexus DQ514312 95
Bacillus sp. DQ416783 96
Bacillus pumilus EU231627 97
Bacillus pumilus EU620415 98
Bacillus pumilus EU231627 99
Bacillus pumilus EF488975 98
Bacillus pumilus EF488975 98
Bacillus pumilus EU624442 98
Janthinobacterium sp. AJ551147 87
Microbulbifer sp. AB243106 98
Uncultured bacterium clone EU491316 95
Halococcus morrhuae clone AM159643 100
Fig. 52. Phylogenetic tree showing the evolutionary position of clones from genomic clone libraries from Puerto de la Libertad 1: V121 ,V148, V157, V130, V22, and V13 in the genus Bacillus. The tree was constructed with the neighbour-joining algorithm. Bar represents the number of substitutions at certain nucleotide sites. Significant bootstrap values from 100 resamplings of the dataset have been included at nodes.
OBJECTIVES:
1. To determine the endophytic microbial diversity associated to healthy tissue of mature, well establish sea grass beds of Thalassia testudinum and Syringodium filiforme from Los Morillos, Buyé Beach, Cayo Enrique, and Puerto de la Libertad by culturing techniques and molecular characterization (environmental genomics). This approach will be useful in assessing both culturable and nonculturable organisms (including bacteria, fungi and possibly archaea). The isolated organisms are going to be critical in constructing the Sea Grass Endophytic Culture Collection (SGECC) that will serve as a reference collection for future research. Data on SGECC will be available on line at the project web page.
2. Determine temporal and spatial distribution, host specificity and seasonality of the endophytic flora associated to healthy tissue of T. testudinum and S. filiforme
3. Improve cultivation and preservation techniques for the endophytic flora recovered.
a. use of the information obtained by environmental genomics (16S rDNA libraries and FISH) to develop culturing strategies for the isolation and cultivation of microorganisms that can not be recovered with conventional culturing methods.
4. Bioprospecting of extra cellular secondary metabolites produced by the endophytic flora recovered.
a. in vitro bioassays will allow the discrimination of bioactive compounds with antimicrobial activities.
5. Facilitate future research on sea grass endophytes by compiling diversity, distributional and temporal data for a linked, online database.
a. Pure cultures will be preserved and deposited at the SGECC established at the Department of Biology at the University of Puerto Rico, Mayagüez Campus (UPR-M) and accession numbers made available online at the project web page.
b. Archaea and bacterial cultures will be cryo-preserved at the Biology Department, UPRM. New strains will be deposited in certified culture collections and the accession numbers will be made available on-line at the project web page.
DISCUSSION OF PROJECT IMPACTS AND PRODUCTS
PROJECT IMPACTS
1. Twelve students impacted during the extent of the project: graduates (Mara Couto and Gloriner Morell) and undergraduates (Marcia Alayón, Alexandra Benítez, Lorena Cuebas, Tavania Espinosa, Agnes Martínez, Coraly Morales, Miguel Ortíz, Roberto Román, Alitza Santiago, and Julia Uzcategui). See Appendix 6.
2. A strong set of molecular tools were develop to study microbial endophytes.
3. We organized and offered three hands-on workshops on February, 2007 (DNA extraction from fungal tissue), April, 2007 (Workshop on PCR
techniques), and January, 2008 (Editing DNA Sequences) for students participating in the project.
4. This research is the first attempt to elucidate the relationship between the anthropogenic activities and the composition of the resident endophytic microbial community.
5. It is also the first attemp to study the relationship between the microbial endophytes inhabiting foliar tissue of T. testudinum.
6. We documented for the first time the role of six different endophytic fungal species inhabiting foliar tissue of T. testudinum. Apparently, these species are mutualistic with the host and coulb be providing important ecological advantages to the host.
7. Documentation of the temporal and spatial distribution of the endophytic microbial diversity (fungi and prokaryotes) associated to surface sterilized foliar tissue of T. testudinum from sea grass beds in Cabo Rojo, Lajas, and Vieques, Puerto Rico.
8. At least four new species were discovered.
9. The first report of the presence of an extremely halophilic archaea as an endophyte in a marine sea grass brings a lot of questions about its role on this environment.
10. The most important impact from this work is that we were able to demonstrate that the microbial composition of T. testudinum can affect its health. We believe that scientists can look at marine microbial ecology now as an important part of marine and coastal conservation. This creates an opportunity to make teams of scientist that can create solutions to preserve this important marine habitat. These findings can also help society to create conscience about marine habitats and how important they are for humanity.
PRODUCTS
1. Establishment of two fully functional laboratories (Extremophiles Laboratory and Aerobiology and Fungal Endophytes Laboratory) equipped with the equipment necessary to study microbial endophytes.
2. Identification catalog of endophytic fungi associated to surface sterilized tissue of Thalassia testudinum (Supplement 1 Catalog of endophytic fungi).
3. Informative flyers (English and Spanish) See Supplements 2 and 3.
4. Creation of the Sea Grass Endophytes Culture Collection (SGECC). This is a collection of cultures of fungal and prokaryotic strains isolated from surface sterilized foliar tissue of Thalassia testudinum and Syringodium filiforme. The SGECC is held in a ultra-low freezer (-80ºC) located at the Fungal Endophytes and Aerobiology Laboratory at B-218-A at the Biology Building.
5. Thesis by supported students:
a. Morell Rodríguez, Gloriner. 2008. Potential of fungal endophytes from Thalassia testudinum Bank ex K.D. Koenig as producers of bioactive compounds.
b. Couto Rodríguez, Mara. Endophytic prokaryotic diversity present in seagrass beds of Thalassia testudinum from Cabo Rojo, Lajas, and Vieques, Puerto Rico. In progress
6. Presentations and technical reports:
a. Technical Report: Informe sobre la diversidad microbiológica endofita en parderas de Thalassia testudinum y Syringodium filiforme de Cabo Rojo, Lajas y Vieques, Puerto Rico submitted to fulfill the dispositions for granting the collection permit 06-C-001. Available upon request.
b. Fifteen (15) presentations (oral and posters)
i. Maldonado-Ramírez, S.L, G. Morell Rodríguez, H. Torres-Pratts, R. Román, M. Ortiz, and C. Morales. 2008. Endophytic fungal diversity in sea grass beds of Thalassia testudinum from sampling sites with different anthropogenic activity histories. 2008 Annual MSA Meeting, Pennsylvania State University, August 9-13, 2008. Contributed presentation.
ii. Maldonado-Ramírez, S.L., A. Santiago Toro, G. Morell Rodríguez, M. Couto, R. Montalvo Rodríguez, S. Wood and A. Miller, Aaron. 2008. Interactions among the endophytic microflora on foliar tissue of Thalassia testudinum (Hydrocharitaceae). 2008 Annual MSA Meeting, Pennsylvania State University, August 9-13, 2008. Poster.
iii. Morell Rodríguez, G., R. Román, M. Ortíz, C. Morales, A. Uzcategui, A. Benítez and S.L. Maldonado Ramírez. 2008. Halotolerant endophytic fungal diversity in sea grass beds of Thalassia testudinum. 2008 Annual MSA Meeting, Pennsylvania State University, August 9-13, 2008. Poster.
iv. M. Couto-Rodríguez, A. Martínez, L. Cuebas, M. Alayón, S. Maldonado-Ramírez and R. Montalvo-Rodríguez. Diversity of endophytic prokaryotes in sea grass beds of Thalassia testudinum from Cabo Rojo, Lajas and Vieques, Puerto Rico.108th General Meeting American Society for Microbiology. Boston, Massachusetts, June 1-5, 2008. Poster.
v. Santiago, A.I., G. Morell Rodríguez, and S.L. MaldonadoRamírez. 2008. Interactions among the endophyutic microflora associated to the foliar tissue of Thalassia testudinum (Hydrocharitaceae). X Simposio de Micología, UT-Caguas, PR. May 2-3, 2008. Oral presentation.
vi. Román, R. and S.L. Maldonado-Ramírez. Endophytic fungal diversity in sea grass beds of Thalassia testudinum in Cabo Rojo, Lajas, and Vieques island. 43rd ACS Junior Technical Meeting and 28th Puerto Rico Interdisciplinary Scientific Meeting, UPRArecibo. March 8, 2008. Oral presentation.
vii. Maldonado-Ramírez, S. L. September 25, 2007. Comparación de la diversidad de hongos endofitos en praderas de Thalassia testudinum en Cabo Rojo, Lajas y Vieques, PR. Department of Biology, UPR-M. Oral presentation.
viii. Román, R., Ortíz, M., Morales, C., G. Morell, and S.L. Maldonado-Ramírez. Halotolerant endophytic fungal diversity in sea grass beds of Thalassia testudinum from Cabo Rojo, Puerto Rico. Halophiles-2007. International Congress Exploring Life at High Salinity. September 2-6, 2007. Colchester, UK. Abstract accepted for presentation, but cannot attend meeting.
ix. Couto-Rodríguez, M. A. Martínez, L. Cuebas, S.L. MaldonadoRamírez, and R. Montalvo-Rodríguez. Endophytic prokaryotic diversity in sea grass beds of Thalassia testudinum from Cabo Rojo, Lajas, and Vieques, Puerto Rico. 107th General Meeting of the American Society for Microbiology. Toronto, Canada. May 21-25, 2007. Poster.
x. Román, R., Ortíz, M., Morales, C., G. Morell, and S.L. Maldonado-Ramírez. Comparison of endophytic fungal diversity in sea grass beds of Thalassia testudinum from Cabo Rojo, Lajas, and Vieques, PR. IX Simposio de Micología. PUCPR, Ponce. May 5, 2007. Poster.
xi. Couto, M., A. Martínez, S.L. Maldonado-Ramírez, and R. Montalvo-Rodríguez. Endophytic microbial diversity in sea grass beds of Thalassia testudinum from Cabo Rojo, Lajas, and Vieques, PR. Sigma Xi XII Poster Day. Chemistry Building, UPR-M. April 26, 2007. Poster.
xii. Maldonado-Ramírez, S.L. and R. Montalvo-Rodríguez. Endophytic Microbial Diversity in Sea Grass Beds of Thalassia testudinum and Syringodium filiforme from Cabo Rojo, Lajas and Vieques, PR. 2nd Annual Symposium for Coastal and Marine Applied Research. Department of Biology, UPR-M, October 5, 2006. Oral presentation.
xiii. Morell Rodríguez, G. and S.L. Maldonado-Ramírez. Isolation of bioactive compounds from endophytic fungi from Thalassia testudinum in Cabo Rojo, PR. 3rd Latin American and Caribbean Biotechnology Congress. Mayagüez Resort and Casino, September 21-22, 2006. Poster.
xiv. Morell Rodríguez, G. and S.L. Maldonado-Ramírez. Aislamiento de compuestos bioactivos de hongos endofitos miceliales recuperados de Thalassia testudinum en Cabo Rojo, PR. IX Congreso Latinoamaericano de Botánica. Santo Domingo, Dominican Republic. June 18-25, 2006. Poster.
xv. Morell Rodríguez, G. and S.L. Maldonado-Ramírez. Aislamiento de compuestos bioactivos de hongos endofitos miceliales recuperados de Thalassia testudinum en Cabo Rojo, PR. VIII Simposio de Micología. IU-Ponce. May 6, 2006. Poster.
RECOMMENDATIONS
After a thorough analysis of the data gathered we strongly feel that:
1. More research is needed to describe and understand the interactions among the endophytic microflora associated to Thalassia testudinum. These interactions might be critical to understand the ecological role of the microflora in the foliar tissue of the host.
2. In vitro tests challenging the microflora isolated the sterilized tissue of T. testudinum are needed to validate preliminary research.
3. In vitro tests in live host tissue is essential to determine the nature and implications of these interactions.
4. A potential area of research to further develop will be the characterization of the secondary metabolites produced by the “protective” fungal species in order to enhance their colonization as a potential tool to improve restoration efforts.
a. We need to fine-tune the initial recovery method in order to increase the concentration of the secondary metabolites as suggested by Dr. Steven Wood.
b. Knowledge of the nature of these compounds will help us to understand the role of the fungal endophytes and might enable us to develop particular/specific management tools to promote the health of the host plant or maybe to work toward the restoration of sea grass beds in highly impacted areas.
c. A. Miller, a graduate student at Dr. Wood’s laboratory recommended a method they have found helpful for extracting antibacterial compounds from a 2 L culture of liquid media. The mat layer on the surface of the liquid culture of the fungus needs to be blend with the liquid media. Then, a solvent such as ethyl acetate or methanol is added to the blended mixture and let the organic and aqueous layers separate. Both organic and aqueous layers are tested to determine which layer contains the bioactive compounds. Next, the solvent can be evaporate off using a roto-evaporator to concentrate the antibacterial extract. The concentrated extract can be further purified using separation techniques such as HPLC
5. We need to expand our in vitro host tests to validate initial observations about the role of certain fungal species associated with T. testudinum.
a. After characterization of the secondary metabolites, these can be used to perform in vitro tests using certain fungal and bacterial strains as well as host tissue.
6. It would be interesting to determine the origin (mode of transmission) of the fungal endophytes recovered from Thalassia testudinum. This information could lead us to formulate new hypothesis regarding the potential interactions between the host plant and other marine organisms or contiguous ecosystems such as coral reefs. For example, Aspergillus sydowii, causal agent of coral bleaching events was reported from our study. Currently we don’t know if the corals are harboring the fungi and the fungi infected the host plant or if the host plant is a reservoir for the opportunistic fungi, waiting for an environmental trigger to infect the coral.
7. By knowing the assemblages of endophytic microorganisms associated with T. testidinum we have a new tool that might help us to be successful in the
implementation of new restauration programs and ecosystem management strategies. Fungal strains of Aspergillus ustus, Cladosporium cladosporioides, Curvularia lunata, and Penicillium janthinellum were isolated from all four sampling sites. Each fungal species has particular attributes that make them excellent candidates for restoration efforts in the field. For example, Aspergillus ustus in terrestrial plants have shown the ability to confer salt tolerance to the host because its ability to grow at different salt concentrations. Isolates of Cladosporium cladosporioides shown their ability to grow at different NaCl concentrations in vitro. Curvularia lunata has been isolated frequently from the marine environments and inhabiting the interior tissues of Porites lutea. Penicillium janthinellum is a producer of a wide array of secondary metabolites, including antibiotics, toxins, and pigments. Having an assemblage of fungal endophytes that includes these species definitely will provide the host with diverse ecological advantages. Also, because the species can co-exist in the limited environment provided by the host we can expect that the interactions between these species have to be beneficial. We can speculate that transplantation of T. testidinum between the sampled sites will not represent a threat to the local sea grass community because these organisms are part of the endophytic assemblages. Also, because their particular characteristics they will be providing the transplanted plants mechanisms to tolerate the salt stress as well as protecting the host because 1) they are already colonizing the tissue and 2) they can produce secondary metabolites that will delay the colonization by other microorganisms, including pathogens.
8. The isolation and identification of endophytic prokaryotes from healthy, mature tissue of sea grasses was the first logical step towards the understanding of their ecological role and importance in this unexplored environment. For example, Pseudoalteromonas sp. has been shown to produce an array of low and high molecular weight compounds with antimicrobial, anti-fouling, algicidal and various pharmaceutically-relevant activities. Compounds formed include toxic proteins, polyanionic exopolymers, substituted phenolic, and pyrolle-containing alkaloids, cyclic peptides and a range of bromine-substituted compounds. Ecologically, Pseudoalteromonas appears significant and to date has been shown to influence biofilm formation in various marine econiches, involved in predatorlike interactions within the microbial loop, influence settlement, germination and metamorphosis of various invertebrate and algal species, and may also be adopted by marine flora and fauna as defensive agents. The genus Pseudomonas was only isolated from Buyé Beach. Species from this genus has been characterized as endophytes and a recent study showed that members of this genus can enhance phytoremediation of herbicides. Also, Exiguobacterium has the ability to degrade phenanthrene, a contaminant that can be present on marine environments due to anthropogenic impact. Using this information as a framework, we can suggest that prokaryotic endophytes are providing the host certain physiological advantages, that might be crucial to the overall health of this marine ecosystem, especially species such as Bacillus spp. that can protect the host against phytopatogenic fungi and has the ability to solubilize phosphorus and nitrogen to be used by the host plant.
BIBLIOGRAPHY
Abrell, L.M., B. Borgeson, and P. Crews. 1996. Chloropolyketides from the cultured fungus (Aspergillus) separated from a marine sponge. Tetrahedron Letters, 37: 2331–2333.
Alker, A.P., G.W. Smith, and K. Kim. 2001. Characterization of Aspergillus sydowii (Thom et Church), a fungal pathogen of Caribbean sea fan corals. Hydrobiologia, 460:105–111.
Aracari Jacometti, N., M.J. Viera Fonseca, and J. Kenup Bastos. 2005. The potencial of an Aspergillis fumigatus Brazilian strain to produce antimicrobial secondary metabolites. Brazilian Journal of Microbiology, 36(4):72-80.
Arnold, A.E., L.C. Mejía, D. Kyllo, E.I. Rojas, Z. Maynard, N. Robbins, and E.A. Herre. 2006. Fungal endophytes limit pathogen damage in a tropical tree. PNAS 100(26):15649-15654.
Arnold E.A., M. Hoffman, M. Gunatilaka, J. Ong, and M. Shimabukuro. 2006. Molecular analysis reveals a distinctive fungal endophyte community associated with foliage of montane oaks in southeastern Arizona. http://www.geo.arizona.edu/anas/ awards/HoffmanMReportANAS06.pdf
Arnold, A.E., D.A. Henk, R. Eells , F. Lutzoni, and R. Vilgalys. 2007. Diversity and phylogenetic affinities of foliar fungal endophytes in loblolly pine inferred by culturing and environmental PCR. Mycologia, 99(2): 185-206.
Athman, S.Y. 2006. Review of the role of endophytes in biological control of plant parasitic nematodes University of Pretoria. http://upetd.up.ac.za/thesis/available /etd-12072006-105803/unrestricted/01chapter1.pdf
Atlas, R.M and R. Bartha. 1998. Microbial Ecology. Fundamentals and Applications. 4th Ed. Benjamin Cummings Science Publishing, Menlo Park, CA. 547pp.
Bacon, C. and J.F. White. 2000. Microbial endophytes. Marcel Dekker, New York, USA. 514pp.
Barka, E.A., S. Gognies, J. Nowak, J.C. Audran, and A. Belarbi. 2002. Inhibitory effect of endophyte bacteria on Botrytis cinerea and its influence to promote the grapevine growth. Biological Control, 24(2):163-170.
Barnett, H.L. and B.B. Hunter. 1987. Illustrated genera of imperfect fungi. 4th Ed. Macmillan Publishing, New York, USA. 218 pp.
Barron, G.L. 1968. The genera of hyphomycetes from soil. William and Wilkins, Baltimore, USA. 200pp.
Bayman, P., L.L. Lebrón, R.L. Tremblay, and D.J. Lodge. 1997. Variation in endophytic fungi from roots and leaves of Lepanthes (Orchidaceae). New Phytologist, 135:143-149.
Bayman, P., P. Angulo-Sandoval, Z. Baéz-Ortiz, and D.J. Lodge. 1998. Distribution and dispersal of Xylaria endophytes in two tree species in Puerto Rico. Mycological Research, 102: 944-948.
Bayman, P. and J. Santamaría. 2005. Fungal epiphytes and endophytes of coffee leaves. Microbial Ecology, 50(1):1-8.
Belofsky, G., P.R. Jensen, M.K. Renner, and W. Fenical. 1998. New cytotoxic sesquiterpenoid nitrobenzoyl esters from a marine strain of the fungus Aspergillus versicolor. Tetrahedron, 54(9):1715–1724.
Benlloch, S., S.G. Acinas, J. Antón, S.P. López-López, and L.F. Rodríguez-Valera. 2001. Archaeal biodiversity in crystallizer ponds from solar salterns: Culture versus PCR. Microbial Ecology, 41:12-19.
Booth, C. 1971. The Genus Fusarium. Commonwealth Mycological Institute, England, Pp.32-35.
Bowman, J.P. 2007. Bioactive compound synthetic capacity and ecological significance of marine bacterial genus Pseudoalteromonas. Marine Drugs, 5(4):220-241.
Caballero, C. 2006. ICBG en Coiba. http://www.stri.org/espanol/acerca_stri/noticias/ avances_cientificos/articulo.php?id=50
Cafaro, M.J. 2005. Eccrinales (Trichomycetes) are not fungi, but a clade of protists at the early divergence of animals and fungi. Molecular Phylogenetics and Evolution, 35(1):21-34.
Calzada, C.M. 1991. El hongo Lindra thalassiae asociado a Thalassia testudinum Banks en La Parguera. In: Departamento de Recursos Naturales de Puerto Rico (Ed.) XVII Simposio de los Recursos Naturales San Juan, PR. 241pp.
Carroll, G.C. 1986. The biology of endophytism in plants with particular reference to woody perennials. In: N.J. Fokema and J. Van den Heuvel (eds.), Microbiology of the phyllosphere, Cambridge University Press, Cambridge. Pp.205-222.
Caroll, G.C. 1988. Fungal endophytes in stems and leaves: From latent pathogen to mutualistic symbiont. Ecology, 69: 2-9
Castillo-Machalskis, I., H.D. Armas, S. Centeno, and M. Ñúñez. 2007. Actividad antibacteriana de extractos de hongos aislados de raíces del mangle Rhizophora mangle en Venezuela. Revista de Biología Tropical, 55(3-4):761-765.
Cenis, J.L. 1992. Rapid extraction of fungal DNA for PCR amplification. Nucleic Acids Research, 20(9): 2380.
Chanway, C.P. 1996. Endophytes: there are not just fungi! Canadian Journal of Botany, 74:321-322.
Chen, G., Y. Lin, L. Wen, L. Vrijmoedc, and E. Gareth. 2003. Two new metabolites of a marine endophytic fungi from an estuarine mangrove on the south China sea coast. Tetrahedron, 59(26):4907-4909.
Chelius, M.K. and E.W. Triplett. 2001. The diversity of archaea and bacteria in association with the roots of Zea mays L. Microbial Ecology, 41: 252-263.
Chun, J., J.H. Lee, Y. Jung, M. Kim, S. Kim, B.K. Kim, and Y.W. Lim. 2007. EzTaxon: a web-based tool for the identification of prokaryotes based on 16S ribosomal RNA gene sequences. International Journal of Systematic and Evolutionary Microbiology, 57:2259-2261.
Cho, K.M., S.Y. Hong, S.M. Lee, Y.H Kim, G.G. Kahng, Y.P. Lim, H. Kim, and H.D. Yun. 2007. Endophytic bacterial communities in ginseng and their antifungal activity against pathogens. Microbial Ecology, 54(2):341-351.
Cowan, S.T. and K.J. Steel. 1965. Manual for the identification of medical bacteria. Cambridge University Press. London. UK.
Dussault, H.P. 1955. An improved technique for staining red-halophilic bacteria. Journal of Bacteriology, 70:484-485.
Dombek, P.E., L.K. Johnson, S.T. Zimmerley, and M.J. Sadowsky. 2000. Use of repetitive DNA sequences and the PCR to differentiate Escherichia coli isolates from human and animal sources. Applied and Enviromental Microbiology, 66:2572–2577.
Edlund, A. and J.K. Jansson. 2008. Use of bromodeoxyuridine immunocapture to identify psychrotolerant phenanthrene-degrading bacteria in phenanthreneenriched polluted Baltic Sea sediments. FEMS Microbiology Ecology. Epub ahead of print.
El-Morsy, E.M. 2000. Fungi isolated from the endorhizosphere of halophytic plants from the Red Sea Coast of Egypt. Fungal Diversity, 5:43 -54.
Espinosa-García, F.J. and J.H. Langenheim. 1991. Effect of some essential oil phenotyppes in coastal redwood on the growth of several fungi with endophytic stages. Biochemical Systematics and Ecology, 19:629-642.
Felsenstein, J. 1993. Philip (Phylogeny Inference Package), version. 3.6. Department of Genetics, University of Washington, Seattle.
Fisher, P.J., F. Graf, L.E. Petrini, B.C. Sutton, and P. A. Wookey. 1995. Fungal endophytes of Dryas octopetala from a high arctic polar semidesert and from the Swiss Alps. Mycologia, 87(3):319-323.
Flores, M. 2007. Seagrass beds suffering from the degradation of coastal water quality. Atlas of the Oceans. http://www.oceansatlas.com/unatlas/uses/uneptextsph/ settleph/2552seagrassbcd.html
Gamboa, M.A., S. Laureano, and P. Bayman. 2002. Measuring diversity of endophytic fungi in leaf fragments: does size matter? Mycopathologia, 156(1):41-50.
Garbeva, P., L. Overbeek, J. Vuurde, and J. Elsas. 2001. Analysis of endophytic bacterial communities of potato by plating and denaturing gradient gel electrophoresis (DGGE) of 16S rDNA based PCR fragments. Microbial Ecology, 41(4):369-383.
García Ríos, C.I. 1990. Guía de Ecosistemas Marinos de Puerto Rico: Las praderas de Thalassia de Puerto Rico. 60 pp.
Germaine, K.J., X. Liu, G.G. Cabellos, J.P. Hogan, D. Ryan, and D.N. Dowling. 2006. Bacterial endophyte-enhanced phytoremediation of the organochlorine herbicide 2,4-dichlorophenoxyacetic acid. FEMS Microbiology Ecology, 57(2):302-310.
Hezayen, F.F., B.J. Tindall, A. Steinbüchel, and B.H.A. Rehm. 2002. Characterization of a novel halophilic archaeon, Halobiforma haloterrestris gen. nov., sp. nov., and transfer of Halobiforma nitratireducers comb. nov. International Journal of Systematic and Evolutionary Microbiology, 52:2271-2280.
Hogan, L.H., B.S. Klein, and S.M. Levitz. 1996. Virulence factors of medically important fungi. Clinical Microbiology Review, 9:469-488.
Höller, U., A.D. Wright, G.F. Matthée, G.M. Konig, S. Draeger, H.J. Aust, and B. Schulz. 2000. Fungi from marine sponges: diversity, biological activity and secondary metabolites. Mycological Research, 104:1354-1365.
Jong, S.C. and M.J. Edwards. 1991. Media Formulation, Catalogue of filamentous fungi. ATCC. 440pp.
Keb-Llanes, M., G. González, B. Chi-Manzanero, and D. Infante. 2002. A rapid and simple method for small scale DNA extraction in Agavaceae and other tropical plants. Plant Molecular Biology Reporter, 20:299a- 299e.
Kendrick, B., M. Risk, J. Michaelides, and K. Bergman. 1982. Amphibious microborers: bioeroding fungi isolated from live corals. Bulletin of Marine Sciences, 32:862–867.
Kishore, G.K., S. Pande, and A.R. Podile. 2005. Phylloplane bacteria increase seedling emergence, growth and yield of field-grown groundnut (Arachis hypogaea L.). Letters in Applied Microbiology, 40(4):260-268.
Klich, M.A. and J.I. Pitt. 1988. A laboratory guide to common Aspergillus species and their teleomorphs. Commonwealth Scientific and Industrial Research Organization, North Ryde, Australia, 114pp.
Koren, O. and E. Rosenberg. 2008. Bacteria associated with the bleached and cave coral Oculina patagonica. Microbial Ecology, 55(3):523-529.
Koser, S.A. 1923. Utilization of the salts of organic acids by the colon-aerogenes group. Journal of Bacteriology, 8: 493-520.
Krohn, K. and M. Ríaz. 2004. Total synthesis of (+)-xyloketal D, a secondary metabolite from the mangrove fungus Xylaria sp. Tetrahedron Letters, 45: 293-294.
Larran, S., A. Perelló, M.R. Simón, and V. Moreno. 2007. The endophytic fungi from wheat (Triticum aestivum L.). World Journal of Microbiology and Biotechnology, 23(4):565-572.
Lin, Y., X. Wu, Z. Deng, J. Wang, S. Zhou, L. Vrijmoed, and E. Gareth. 2002. The metabolites of the mangrove fungus Verruculina enalia No.2606 from a salt lake in The Bahamas. Phytochemistry, 59:469-471.
Lodge, D.J., P.J. Fisher, and B.C. Sutton. 1996. Endophytic fungi of Manilkara bidentata leaves. Mycologia, 88(5):733-738.
Lucero, M. 2007. Identification of seed borne endopohytes that confer salt tolerance to host plants. Botany and Plant Biology 2007 Joint Congress http://www.2007.botanyconference.org
Magnuson, J. and L.Lasure. 2004. Organic acid production by filamentous fungi. In: Advances in Fungal Biotechnology for Industry, Agriculture, and Medicine Kluwer Academic & Plenum Publishers, New York. Pp.307-340.
Malavé Vega, S. 2006. Catastro de hongos endófitos miceliales en la yerba marina Thalassia testudinum Bank ex Köing de Buyé, Cabo Rojo, Puerto Rico. Thesis, University of Puerto Rico, Mayagüez, PR. 76pp.
Maldonado, S. L., J. Leiva, and B. Quiñones. 2003. Preliminary studies of fungal endophytes in Thalassia testudinum. Puerto Rico Louise Strokes Alliance for Minority Participation. http://www.prlsamp.org/what_is_prlsamp/Major_ _Events/PRISM/2003/Abstract/biology.htm.
Mäntynen, V.H. 1999. Detection, quantification and characterization of food related microorgasims using molecular and physiological methods. Department of Applied Chemistry and Microbiology. University of Helsinki, Finland. 66pp.
Manire, C.A., H.L. Rhinehart, D.A. Sutton, E.H. Thompson, M.G. Rinaldi, J.D. Buck, and E. Jacobson. 2002. Disseminated mycotic infection caused by Colletotrichum acutatum in a Kemp’s Ridley sea turtle (Lepidochelys kempi). Journal of Clinical Microbiology, 40(11):4273–4280.
Mok, T., A.P. Koehler, M.Y. Yu, D.H. Ellis, P.J. Johnson, and N.W. Wickham. 1997. Fatal Penicillium citrinum pneumonia with pericarditis in a patient with acute leukemia. Journal of Clinical Microbiology, 35(10):2654-2656.
Montalvo-Rodríguez, R., Vreeland, R.H., Oren, A., Kessel, M., Betancourt, C., and J. López-Garriga. 1998. Halogeometricum borinquense gen. nov., sp. nov., a novel halophilic archaeon from Puerto Rico. International Journal of Systematic Bacteriology, 48:1305-1312.
Morales, R. and M. González. 2006. Hongos endofitos en plantaciones de mango Haden' de la planicie de Maracaibo, Venezuela. Revista de la Facultad de Agronomía, 23(3):273-284.
Moore, D.R. 1963. Distribution of the sea grass Thalassia in the United States. Bulletin of Marine Science of the Gulf and Caribbean, 13(2):329-342.
Mukherjee, I. and A. Mittal. 2006. Bioremediation of endosulfan using Aspergillus terreus and Cladosporium oxysporum. Bulletin of Environmental Contamination and Toxicology, 75(5):1034-1040.
Page, R.D.M. 1996. Treeview: an application to display phylogenetic trees on personal computers. Computer Applied Biosciences, 12:357–358.
Petrini, O. 1987. Taxonomy of endophytic fungi of aerial plant tissues. In: Microbiology of the phyllosphere. N. J. Fokkema and J. van den Heuvel (Eds.). Cambridge University Press, Cambridge, UK. Pp.175-187.
Petrini, O. 1991. Fungal endophytes of tree leaves. In: Microbial ecology of the leaves, J.H. Andrews and S.S. Hirano (Eds.), Springer, New York, USA. Pp.175-187.
Piontelli, E.L., M.A. Toro, G. Giusiano, and M. Valia. 2002. Distribución altitudinal de hongos queratinofilos, epífitos y endofitos en suelos deserticos del norte chileno. Boletín Micológico, 17:33–49.
Pitt, J.I. 1985. A laboratory guide to common Penicillium species. Commonwealth Scientific and Industrial Research Organization, North Ryde, Australia, 184pp.
Rademaker, J.L.W. and F.J. de Bruijn. 1997. Characterization and classification of microbes by rep-PCR genomic fingerprinting and computer assisted pattern analysis. In: DNA markers: protocols, applications, and overviews. G. CaetanoAnolle´s and P.M. Gresshoff (Eds.). J. Wiley and Sons, New York, Pp. 151–171.
Raghukumar, C., S. Raghukumar, S. Sharma, and D. Chandramohan. 1988. Endolithic fungi from deep-sea calcareous substrata: isolation and laboratory studies. In: Marine biodeterioration, M. Thompson and R. Sarojini (Eds). Routledge, New York, USA. Pp.693–702
Raghukumar, C. and S. Raghukumar. 1991. Fungal invasion of massive corals. Marine Ecology, 12(3):251–260
Raghukumar, C. 1996. Zoosporic fungal parasites of marine biota. In: Advances in zoosporic fungi. R. Dayal (Ed). M.D. Publications, Pvt. Ltd, New Delhi, Pp.61–83.
Raghukumar, C. and S. Raghukumar. 1998. Barotolerance of fungi isolated from deepsea sediments of the Indian Ocean. Aquatic Microbial Ecology, 15:153–163
Raghukumar, S. and C. Raghukumar. 1999. Marine fungi: a critique. Aquatic Microbiology Newsletter, 38:26–27
Ramírez, J., E. Delgado, M. Rodolfi, and T. Solveig. 2006. Actividad antagónica de hongos endofitos de plantas medicinales del Ecuador sobre bacterias patógenas. Boletín Micológico, 21:49-53.
Raper, K.B. and D.I. Fennel. 1965. The genus Aspergillus. Williams & Wilkins. Baltimore, MD, USA.
Rasche, F., R. Trondl, C. Naglreiter, T.G. Reichenauer, and A. Sessitsch. 2006. Chilling and cultivar type affect the diversity of bacterial endophytes colonizing sweet pepper (Capsicum anuum L.). Canadian Journal of Microbiology, 52(11):10361045.
Ravindran, J. and C. Raghukumar. 2001. Fungi in Porities lutea: association with healthy and diseased corals. Diseases of Aquiatic Organisms, 47: 219-228.
Reva, O.N., V.V. Smirnov, B. Petterson, and F.G. Priest. 2002. Bacillus endophyticus sp. nov., isolated from the inner tissues of cotton plants (Gossypium sp.). International Journal of Systematic and Evolutionary Microbiology, 52:101-107.
Riddell, R. W. 1950. Permanent stained mycological preparation obtained by slide culture. Mycologia, 42:265-270.
Roth, F. J., P. A. Orpurt, and D. G. Ahearn. 1964. Occurrence and distribution of fungi in a subtropical marine environment. Canadian Journal of Botany, 42: 375–383.
Rubino, M. 2005. Diversity of endophytic fungal community of cacao (Theobroma cacao L.) and biological control of Crinipellis perniciosa, causal agent of Witches' Broom Disease. International Journal of Biological Sciences, 1(1): 24–33.
Rusznyák, A. G. Szabó, B. Pollák, V. Vágány, and M. Palatinszky. 2007. Diversity of reed (Phragmites australis) stem biofilm bacterial communities in two Hungarian soda lakes. Acta of Microbiology and Immunology of Hungary, 54(4):339-352.
Rützler, K., D.L. Santavy, and A. Antonius. 1983. The black-band disease of Atlantic reef corals III. Distribution, Ecology, and Development. PSZNI Marine Ecology, 4:301-319.
San-Martín, A., K. Painemal, Y. Díaz, C. Martínez, and J. Rovirosa. 1985. Metabolites from the marine fungus Cladosporium cladosporioides Journal of the Argentine Chemical Society, [online]. ago./dic. 2005, vol.93, no.4-6 [citado 27 Julio 2008], p.247-251. http://www.scielo.org.ar/scielo.php?script=sci_arttext&pid=S036503752005000200020&lng=es&nrm=iso>. ISSN 0365-0375.
Schardl, C.L., A. Leuchtmann, K.R. Chung, D. Penny, and M.R. Siegel. 1997. Coevolution by common descent of fungal symbionts (Epichloë spp.) and grass hosts. Molecular Biology and Evolution, 14:133-143.
Schultz, B., A.K. Romert, U. Dammann, H.J. Aust, and D. Strack. 1999. The endophyte-host interaction: a balance antagonism?. Mycological Research, 103(10):1275-1283.
Seifert, K.A. 2000. A novel method of growing fungi for DNA extraction. Center for Land and Biological Resources Research-Agriculture Canada, Research Branch, Ottawa, Canada. http://www.fgsc.net/fgn41/seifert.html
Shearer A.E.H., A.S. Mazzotta, R. Chuyate, and D.E. Gombas. 2002. Heat resistance of juice spoilage microorganisms. Journal of Food Protection, 65:1271-1275.
Simmons, J. S. 1926. A culture medium for differentiating organisms of typhoid-colon aerogenes groups and for isolation of certain fungi. Journal of Infectious Diseases, 39:209.
Sivanesan, A. 1987. Graminicolous species of Bipolaris, Curvularia, Drechslera, Exserohilum and their teleomorphs. 1987. CAB International Mycological Institute, U.S. 261pp.
Soto-Ramírez, N., C. Sánchez-Porro, S. Rosas-Padilla, K. Almodóvar, G. Jiménez, M. Machado-Rodríguez, M. Zapata, A.Ventosa, and R. Montalvo-Rodríguez. 2008. Halobacillus mangrovi sp. nov., a moderately halophilic bacterium isolated from the black mangrove Avicennia germinans. International Journal of Systematic and Evolutionary Microbiology, 58 (Pt 1):125-130.
Sridhar, K.R. and N.S. Raviraja. 1995. Endophytes- a crucial issue. Current Science, 69(7):570-571.
Sweeney, J.C., G. Migaki, P.M. Vainik, and R.H. Conklin. 1976. Systemic mycoses in marine mammals. Journal of the American Veternary Medicine Association, 169:946–948.
Sziderics, A.H, F. Rasche, F. Trognitz, A. Sessitsch, and E. Wilhelm. 2007. Bacterial endophytes contribute to abiotic stress adaptation in pepper plants (Capsicum annuum L.). Canadian Journal of Microbiology, 53(11):1195-1202.
Thomas, P., S. Kumari, G.K. Swarna, and T.K. Gowda. 2007. Papaya shoot tip associated endophytic bacteria isolated from in vitro cultures and host-endophyte interaction in vitro and in vivo. Canadian Journal of Microbiology, 53(3):380390.
Toro, M., R. Azcon, and J. Barea. 1997. Improvement of arbuscular mycorrhiza development by inoculation of soil with phosphate-solubilizing rhizobacteria to improve rock phosphate bioavailability ((sup32)P) and nutrient cycling. Applied Environmental Microbiology, 63(11):4408-4412.
Ulrich, H.O., A.D. Wright, G.F. Matthe, G.M. Konig, S. Draeger, H.J. Aust, and B. Schulz. 2000. Fungi from marine sponges: diversity, biological activity and secondary metabolites. Mycological Research, 104(11):1354-1365.
Vega, F.E., M. Pava-Ripoll, F. Posada, and J.S. Buyer. 2005. Endophytic bacteria in Coffea arabica L. Journal of Basic Microbiology, 45(5):371-380.
Vega, F.E. and F. Posada. 2006. Penicillium species endophytic in coffee plants and ochratoxin A production. Mycologia, 98(1): 31-42.
Velázquez, E., M. Rojas, M.J. Lorite, R. Rivas, J.L. Zurdo-Piñeiro, M. Heydrich, and E.J. Bedmar. 2008. Genetic diversity of endophytic bacteria which could be find in the apoplastic sap of the medullary parenchym of the stem of healthy sugarcane plants. Journal of Basic Microbiology, 48(2):118-124.
Versalovic, J., F.J. de Bruijn, and J.R. Lupski. 1998. Repetitive sequence-based PCR (rep-PCR) DNA fingerprinting of bacterial genomes. In: Bacterial genomes: physical structure and analysis. F.J. de Bruijn, J.R. Lupski, and G.M. Weinstock (Eds.). Chapman and Hall, New York, Pp. 437–454.
Vladár, P., A. Rusznyák, K. Márialigeti, and A.K Borsodi. 2008. Diversity of sulfatereducing bacteria inhabiting the rhizosphere of Phragmites australis in Lake Velencei (Hungary) revealed by a combined cultivation-based and molecular approach. Microbial Ecology, 56(1):64-75.
Wang, J., Y. Huang, M. Fang, Y. Zhang, Z. Zheng, Y. Zhao, and W. Su. 2002. Brefeldin A, a cytotoxin produced by Paecilomyces sp. and Aspergillus clavatus isolated from Taxus mairei and Torreya grandis. FEMS Immunology and Medical Microbiology, 34 (1): 51-57.
Wang, Y.T., H.S. Lo, and P.H. Wang. 2008. Endophytic fungi from Taxus mairei in Taiwan: first report of Colletotrichum gloeosporioides as an endophyte of Taxus mairei. Botanical Studies, 49: 39-43.
Wilson, W.L. 1996. Isolation of endophytes from sea grasses from Bermuda. Thesis. University of New Brunswick. 83pp.
Yoon, J.-H., S.H. Choi, K.C. Lee, Y.H. Kho, K.H. Kang, and Y.H. Park. 2001. Halomonas marisflavae sp. nov., a halophilic bacterium isolated from the Yellow Sea in Korea. International Journal of Systematic and Evolutionary Microbiology, 51:1171-1177.
Zalar, P., G.S. de Hoog, H.J. Schroers, P.W. Crous, J.Z. Groenewald, and N. GundeCimerman. 2007. Phylogeny and ecology of the ubiquitous saprobe Cladosporium sphaerospermum, with descriptions of seven new species from hypersaline environments. Studies in Mycology, 58(1):157–183.
APPENDICES
Appendix 1: PCR cycles
Place the PCR tubes in the PCR machine. The reactions will follow these parameters: 95 °C for 2 min., 95 °C for 1 min., 56 °C for 1 min., 72 °C for 1 min., 30 repetitions starting with the second cycle (95 °C for 1 min), 72 °C for 5 min., and set up END. After completion of all the cycles, the tubes can be stored at -20°C.
Appendix 2: Clean-up of PRC reaction
1. Place 0.5µl of ExoSap in the tube containing the PCR product and mix gently.
2. Incubate at 37 °C for 15 min.
3. Incubate at 65 °C for 15 min.
Appendix 3: DNA extraction from plant tissue
1. Macerate the sample in 200 µl of the extraction buffer adding a pinch of PVP to each sample before macerating with sterile sand.
2. Add 600µl of isoamyl-chloroform 24:1 and heat in a water bath at 65°C for 15min.
3. Mix by inmersión for 15 min and centrifuge for 10 min. at 13,000 rpm.
4. Extract 450 µl of the supernatant and place in a 1.5ml tube.
5. Add 2/3 of the volume of cold isopropyl alcohol (-20°C).
6. Add 1/10 of the volume of cold ammonium acetate (-20°C).
7. Mix by inmersión and store at -20°C overnight.
8. The next day, centrifuge for 10 min. at 13,000 rpm, discard the supernatant, and place the tubes over towell paper.
9. Clean the pellet in 400µl of 70% cold ethanol (-20°C) and centrifuge at 13,000 rpm for 10 min.
10. Discard the ethanol and let it dry for one hour.
11. Resuspend the pellet in 150 µl of RNAse-water (826 µl of ditilled water + 10 µl of Tris HCL 1M + 164 µl of liquid RNAse).
12. Place the tubes is a water bath for 15 min. at 65°C.
13. Test the DNA quality in a 0.8% agarose gel.
14. Read the DNA concentrations and dilute if necessary.
Appendix 4: DNA purification using the Puregene DNA purification kit from 0.5-2.0mg solid tissue.
Cellular Lysis
1. Add 0.5-2.0mg of frozen tissue stored at -70° to -80°C in a 1.5 ml microtube containing 100 µl of Cell Lysis Solution.
2. Remove from ice, ad homogenize thoroughly using a microfuge tube pestle. Place sample back on ice until the next step.
3. Incubate lysate at 65°C for 15min. Alternatively, if maximum yield is required, add 0.5µl of Proteinase K Solution to the lysate. Mix by inverting 25 times and incubate at 55°C for 3 hours to overnight.
4. The next day remove the tubes from the incubator and let them cool for few seconds.
Cleaning of the genetic material
A. RNase treatment
1. Add 0.5µl of RNase A Solution (4mg/ml) to the cell lysate.
2. Mix the sample by inverting the tube 25 times and incubate at 37°C for 15-60 min.
B. Protein precipitation
1. Cool sample at room temperature.
2. Add 33µl of the Protein Precipitation Solution to the RNase A-treated cell lysate.
3. Vortex vigorously at high speed for 20 sec to mix the Protein Precipitation Solution uniformly with the cell lysate. Place the samples on ice for 5 min.
4. Centrifuge at 13,000-16,000 rpm x g for 3 min. The precipitated proteins will form a tight pellet. If the protein pellet is not visible, repeat Step 3 followed by incubation on ice for 5min, the repeat Step 4.
C. DNA Precipitation
1. Pour the supernatant containing the DNA (leaving venid the precipitated protein pellet) into a clean 1.5ml centrifuge tube containing 100µl 100% Isopropanol. If the DNA yield is expected to be low (<1µg), add a DNA carrier such as Gentra Glycogen Solution to the 100µl isopropanol.
2. Mix the sample by inverting gently 50 times.
3. Centrifuge at 13,000-16,000 rpm x g for 5 min.
4. Pour the supernatant and drain tube on clean absorbent paper. Add 100µl of 70% ethanol and invert tube several times to wash the DNA pellet.
5. Centrifuge at 13,000-16,000 rpm x g for 1 min. Carefully pour off the ethanol. Pellet may be loose so pour slowly and watch pellet.
6. Invert and drain the tube on clean absorbent paper and allow to dry 10-15min.
D. DNA re-hydration
1. Add 20µl DNA Hydration Solution (20µl will give a concentration of 50ng/µl if the total yield is 1µg DNA).
2. Rehydrate DNA by incubating sample one hour at 65°C and/or overnight at room temperature. If posible, tap tube periodically to aid in dispensing the DNA.
3. Store DNA at 4°C. For long-term storage, store at -20°C or -80°C.
Appendix 5: DNA sequences for fungal endophytes isolated from surface sterilized tissue of Thalassia testudinum.
Fungal endophyte
DNA sequence edited
Aspergillus niger GGGAGGTGGGCGGCTGCGTACTGTGCCCAAGATTTCCAGACAGGCAGC ATGGAAAGTCGCCTTCGTGGCCAAGTTGTCTCTAGCTTAACGCGTCCA GGATCAATGATGGCTGTTGGCCTGAGCCCAGACCTACACATATCTTGC AGGGGTGCAGCAAAGTGCGAGCGGGGTATTGACTATTGCATGTTTTAA TAGAAACAGTATCCGGCGACAGCGCCATGGTCATGCCCTCAAGAGCTT GCTGGACGCAAAGCGAATT
Alternaria tenuissima TCCGACGTTGCCGTCCCTTCAGGCACAACTTTGGACCTCTCTAGTCTGG CTGACGGTACTACTGTCATCTTCGAGGGTACCACCACGGCTACTCGGA ATGGAAGGTCCCCTTCTTGACATCCAAGGAAAGAAGACACTGTCAGGC GCCGAGGGATCTGTTCT
Curvularia pallecens CCTCTCCGTAGGGGAACCTGAACCTGCGGGAGGGGATTACAAGTGACC CCCGGTTACCACCGGGATGTTCATAACCCTTTGTTGTCCGACTCTGTTG CCTCCGGGGCGACCCTGCCTTCGGCGGGGGCTCCGGGTGGACATCTCT TGGTTCTGGCATCGATGAAGAACG
Phytophtora sp. CGTGAACCGTATCAAAACTTAGTTGGGGGTCTCTTTCGGCGCGGCTGC TGGCTTCATCTGGCGGCTGCTGTTGGGAGACTATCATGGCGAGCGTTT GGGCTTCGGTCTGAACTAGTAGCTTTTTTAAACCCATTCTTTATAAATT ATACTGTAGGGACGAAAGTCTCTGCTTTTAACTAGAGCAACTTTCAGC AGTGGATGTCTCTCGCACATCGA
Oidium sp. ATTACAGAGTGAGGCTCAGTCGTGGCATCTGCTGCGTGCTGGGCCGAC CCTCCCACCCGTGTCGAGTATCTTGTTGCTTTGGCGGGCCGGGCCGCGT CGTCGCTGCCCCGCAAGGACAAGCGCCGCCCACCGGTTTCGGCTGGAG CGCGCCCGCCAAAGACCCCATCAAAACTCATGTTTATGTCGTTTAGCTT TATTATTGAAATTGATAAAACTTTCAACAACGGATCTCTTGGC
Cladosporium sphaerospermum ATCATTACAAGTGACCCCCGGCTCCGGCCGGGGATGTTCATAACCCTT TGTTGTCCGACTCTGTTGCCTCCGGGGCGACCTGCCTTTTCACGGGCGG GGGCCCCGGGTGGACACATCAAAACTCTTGCGTAACTTTGCAGTCTGA GTAAATTTAATTAATAAATTAAAACTTTCAACAACGGGATCTCTTGGTT CTGGCATCGATGAAGAACGCAGATAAGTAATGTGAATAACGCACATT Bipolaris sp. TGCGGAGGGATCATTACACAAAAAGTATGAAGGCTGCACGCGGCTGG ATTATCTTTTTCACCCATGTCTTTTGCGCACTTTGTTTCCTGGGCGGGTT CGCCCGCCACCAGGACCACACAATAAACCTTTTTTTATGCAGTGCAAT CACGTCAGTAAAACAAAAAATCATTTACAACTTTCAACAACGGATCTC TTGGCATCGATGAAGAACGCAGCGAAATGCGAATACGTAGTGTGAATT GCAGAAT
Aspergillus ustus AGCGGGTGACAAAGCCCCATACGCTCGAGGATCcGACGCGGTGCCGCC GCTGCCTTTCGGGCCCGTCCCCCCCGGGGGGGGGACGACGACCCAACA CACAAGCCGGGCTTYASGGCAGCAATGACGCTCGGACAGGCATGCCCC CCGGAATACCAGGGGGCGCAATGTGCGTTCAAAGACTCGATGATTCAC TGAATTCTGCAATTCACATTAGTTATCGCATTTCGCTGCGTTCTTCATC GATGCCGGAACCAAGAGATCCATTGTTGAAAGTTTTAACTGATTGCAA AGAATCAACTCAGACTGCATGCTTTCAGACAGTGTTCGTGTTGGGGTC TTCGGCGGGCACGGGCCCGGGGGGCAGAGCCCCCCCGGCGGCCGACA GGCGGCGGGCCCGCCGAAGCAACATGGTACGGTAGACACGGGTGGGA GGTTGGGCCCCGAAGGACCCGCACTCGGTAATGATCCTTCCGCAGGTT CACCTACGGAAGGATCATTACCGAGTGCGGGTCCTTCGGGGCCCAACC TCCCACCCGTGTCTACCGTACCATGTTGCTTCGGCGGGCCCGCCGCCTG TCGGCCGCCGGGGGGGGCTCTGCCCCCCGGGCCCGTGCCCGCCGAAGA CCCCAACACGAACACTGTCTGAAAAGCATGCAGTCTGAGTTGATTCTT TGCAATCAGTTAAAACTT
Fungal endophyte
Cladosporium cladosporoides
Cladosporium oxysporum
DNA sequence edited
TCCTCCGCTTATTGATATGCTTAAGTTCAGCGGGTATCCCTACCTGATC CGAGGTCAACCTTAGAAATGGGGTTGTTTTACGGcGTAGCCTCCCGAA CACCCTTTAGCGAATAGTTTCCACAACGCTTAGGGGACAGAAGACCCA GCCGGTCGATTTGAGGCACGCGGCGGACCGCGTTGCCCAATACCAAGC GAGGCTTGAGTGGTGAAAtGACGCTCGAACAGGCATGCCCCCCGGAAT ACCAGGGGGCGCAATGTGCGTTCAAAGATTCGATGATTCACTGAATTC TGCAATTCACATTACTTATCGCATTTCGCTGCGTTCTTCATCGATGCCA GAACCAAGAGATCCGTTGTTAAAAGTTTTAATTTATTAATTAAGTTTAC TCAGACTGCAAAGTTACGCAAGAGTTTGAAGTGTCCACCCGGAGCCCC CGCCCGAAGGCAGGGTCGCCCCGGAGGCAACAGAGTCGGACAACAAA GGGTTATGAACATCCCGG
ACGGCGCCGCCTCCtGAGCACCCATTAGCGAATAGTTTCCACAACGCTT AGGGGACAGAAGACCCAGSSGGTCGATTTGAGGCACGCGGCGGACCG CGTTGCCCAATACCAAGCGAGGCTTGAGTGGTGAAATGACGCTCGAAC AGGCATGCCCCCCGGAATACCAGGGGGCGCAATGTGCGTTCAAAGATT CGATGATTCACTGAATTCTGCAATTCACATTACTTATCGCATTTCGCTG CGTTCTTCATCGATGCCAGAACCAAGAGATCCGTTGTTAAAAGTTTTA ATTTATTAATTAAGTTTACTCAGACTGCAAAGTTACGCAAGAGTTTGA AGTGTCCACCCGGAGCCCCCGCCCGAAGGCAGGGTCGCCCCGGAGGC AACAGAGTCGGACAACAAAGGGTTATGAACATCCCGGTGGTTAGACC GGGGTCACTTGTAATGATCCCTCCGCAGGTTCTCCTACGGAG
Phoma sp. TGAGCCAAAGGGGCATACTCGGATCTGATACGGCACCTTTGCCTTTGA TCGCCTTATAGTTTCCACGTGCAGACTCGCCCGCCGTTGCACCTCCAAA AAAACCCCTTGTGCCGGCCGATCTTCTGATGAAAAGAAAATAGCCACA ACTTTCAACAACGAGTCTCTTGGTTCTGGCATCGATGAATAACGAAAT GAAATGCGATAAGGAGTGCGCATTGCAAAACTCAATGAATCATCGAAT CTTTGAACATTCATTGATTCCTGAATTCTCCGTTCACACTGCCTGTCCG AGTGCCCTGCGAAAATTCTCGATCCCATAGCCGATGGATCCTTGGCTG CCCCTTCTGACTATTTGCTTTTTATTCATGAAATGCTGCTATTACTGGG GGCTTCGAGGGATGTCCACCGGCGGCCGAGCCCTGGAAGTGCACGGA ATGCCACTAAAAGGACTTGGAGCGCTTGCCCACGGAACATTGACCCAC ACCCGCTATGATCCTTCAGATCGATCACCTAAGGAATCTTACCGTTGG AGGTCAAACTCCCATCGGGATAGACACCCTTGCCTTTGAGTACCTTTTC GTTTCCTCGGCGGGCTCGCCCGGGGGGGAATCCAAAAAAACCCTTTGT AATAGCGTTTTCTCTGAAAAAAAACAATATTCACACTTTTACCACGGA TTCTTTGGTTCGGCTTCTAGAAAAACCACCAAAGTCAAAGAGTGGGGG
Curvularia pallescens GGGGGGAAGAAAAAGCCCGGGGGGATGGGGTGCAACAAAAAACCCT GGAGGAAGCGCCCTTGTTTTttTTtGGGCGGAATCGCCCGCAGCAGGGAc ACACCAtATTCTGTTTTGTAACGCTGTCAGCGTCAGCTCTACAAAGTAA AACAATTAGAACTTTCAACAGCAGATCTCTTGGTTCTGA
Gliocephalis hyalina
GCTCCAAAGCGTATATTAAAGTTGTTGCAGTTAAAAAGCTCGTAGTTG AACTTTGGTCTCGGCTGGCCGGTCCGCCTCACCGCGTGTACTGGTCTGG CTGGGACTTTCCTCTTGGGGAACCGCATGCCCTTTACTGGGTGTGTTGG AAACCAGGACTTTTACTTTGAAAAAATTAGAGTGTTCAAAGCAGGCAA TTGCTCGGATACATTAGCATGGAATAATAAATAGGACGTGTGGT
Penicillium citrinum CCTTGGGGCCACCTCCCACCCGTGTTGCCCGAACCTATGTTGCCTCGGC GGGCCCCACACCCGCCGACGGCCCCCCTGAACGCTGTCTGAAGTTGCA GTCTGAGACCTATAACGAAATTAGTTAAAACTTTCAACAACGGATCTC TTGGTTCCGGCATCGATGAAGAACGCAGCGAAATGCGATAACTAATGT GAATTGCAGAATTCAGTGAATCATCGAGTCTTTGAACGCACATTGCGC CCTCTGGTATTCCGGAGGGCATGCCTGTCCGAGCGTCATTGCTGCCCTC AAGCCCGGCTTGTGTGTTGGGCCCCGTCCCCCCCGCCGGGGGGACGGG CCCGAAAGGCAGCGGCGGCACCGCGTCCGGTCCTCGAGCGTATGGGG CTTCGTCACC
Fungal endophyte DNA sequence edited
Penicillium janthinellum
Penicillium miczynski
ACGCACATTGCCGCCCCCTGGTATTCCGGGGGGCATGCCTGTCCG AGCGTCATTGCTGCCCTCAAGCACGGCTTTGGTGTGTTGGGGCTC CGCCCCCCTCCCGGGGGGCGGGCCCGAAAGGCAGCGGCGGCACC GCGTCCGG
TGGGGGGAGGAAAAGGAGTATTGGATCTTCTTCCTGCCGTGAAAA TTTGACCTGGAAGCTTCCGTCGTCCTGCCTTTACTGGCCGCCGGGG GGAAAACGTACCCTCTACCGCGCCCGCCGAACCACCCCCGAACTC TGTCTGAAGATTGAAGTCTGAGAGAAAATATAAATTATTTAAAAC TTTCAACAACGCATCTCTTGACTCCGGCATCGATGAACAACGCGG AGAACTGCGATACGTAATGTGAATTGCAAAATTCGATGATCATCT GAGTCGATGAACGCTCATTGCGCCCCCTGTTATTCCGGGTCGTCT GCCTGTCCGAACCTCATTGCTGCCCTGAAGACCGGTTTAAGTGAT GTATATTTTCCTAATCCTTCAATCTTCCGACAAAGTAGGGGCGCCC TT
Scolecobasidium constrictum CATGACTAAAAGTATAAGCAACTATACTGTGAAACTGCGAATGGC TCATTAAATCAGTTATCGTTTATTTGATAGTGCCTTACTACTTGGA TAACCGTGGTAATTCTAGAGCTAATACATGCTAAAAACCCCGACT CGGAGGGGGTGTATTTATTAGATAAAAAACCAATGCCCTTCG GGCTGCTTGGTGAATCATAACTTAACGAATCGCATGGCCTTGCGC CGGCGATGGTTCATTCAAATTTCTGCCCTATCAACTTTCGATTGTA GTTTAGTGGACTACAATGGTTTCAAC
Aspergillus versicolor AACTCCcGCTYTTTTAWGGCcGACGGTGCCCGCACAACCCTGCGG GCCCCCGGGCGCCAATGGAAAAGCGGGTGACAMAGCCCCATACG CTCGAGGACCTAGAAAGAGGGCCGCCGCTGCCTACCAGGCCCGT CCCCSGGGGGGG
Curvularia lunata TCGGCTGGATTATTTATTTCACCCTTGTCTTTTGCGCACTTGTTGTT TCCTCGTGGGTTCGCCCGCCACCAGGACCACACCATAAACCTTTT TTGTTAATGCAGTCAGCGTCAGTACAACAAATGTAAATCATTTAC AACTTTCAACAACGGATCTCTTGGTTCTGGCATCGATGAAGAACG CAGCGAAATGCGATACGTAGTGTGAATTGCAGAATTCAGTGAATC ATCGAATCTTTGAACGCACATTGCGCCCTTTGGTATTCCAAAGGG CATGCCTGTTCGAGCGTCATTT
Hortaea wernekii
AATGGCTCATTAAATCAGTTATCGTTTATTTGATAGTACCTTACTA CATGGATAACCGTGGTAATTCTAGAGCTAATACATGCTAAAAACC CCGACTTCGGGAGGGGTGTATTTATTAGATAAAAAACCAATGCCC TTCGGGGCTCCTTGGTGAATCATAATAACTTAACGAATCGCATG
Trichoderma reseii GGTCACCTCCGACGGCAGCGTCTACGACATTTACCGCACGCAGCG CGTCAACCAGCCGTCCATCATCGGCACCGCCACCTTTTACCAGTA CTGGTCCGTCCGCCGCAACCACCGCTCGAGCGGCTCCGTCAACAC GGCGAACCACTTCAA
Trichoderma spirale TCAAAACTTTCAACAACGGATCTCTTGGTTCTTGGCATCGAGTGA ATTGCAGAATTCAGTG
Paecilomyces variotii AAGGATCATTACCGAGTGAGGGTCCCTCGGGGCCCAACCTCCCCA TCCGTGTTGTCCTGAACCTGTTGCTTCGGCGGGCCCGCCGTGGTTG ACCCCTGGAACGCTGCCTGGAAGGTTGCCGTCTGAGTAACAATCA ATCAATTAAAACTTTCAACAACG
Botrytis sp. TTTATTAATGTCGTCTGAGTACTATATAATAGTTAAAACTTTCAAC AACGGATCTCTTGGTTCTGGCATCGATGAAGAACGCAGCGAAATG CGATAAGTAATGTGAATTGCAGAATTCAGTGAATCATCGAATCTT TGAACGCACATTGCGCCCCTTGGTATTCCGGGGGGCATGCCTGTT CGAGCGTCATTTCAACCCTCAAGCTTAGCTTGGTATTGAGTCTATG TCAGTAATGGCAGGCTCTAAA
Fungal endophyte DNA sequence edited
Curvularia brachyspora ATATGAAGGCTGCACGCGGCTGTGTCTCCGGGCCAGTTTGCTGAG GCTGAATTATTTTTCACCATGTCTTTTGCGCACTTGTTGTTTCCTTG GTTCTGGCATCGAGAGAACGCAGCGAAATGCGATA
Penicillium janthinellum
Nigrospora sp.
ACGCACATTGCCGCCCCCTGGTATTCCGGGGGGCATGCCTGTCCG AGCGTCATTGCTGCCCTCAAGCACGGCTTTGGTGTGTTGGGGCTC CGCCCCCCTCCCGGGGGGCGGGCCCGAAAGGCAGCGGCGGCACC GCGTCCGG
GGCTGAGGTCATTAAAAGAGCTGTGGGCATGCTCCACACGGCGTC GCTGCTCATTGATGATATCCAAGACAATTCCGAGTTGCGACGAGG ACGGCCTGTCGCCCACAAGATCTTCGGCCCGGCCATGACCATCAA TCGGCGAACCACATGTACTTCCTGGCCCTACAGGAGCTGAATGCC TGGGAAACCCCCGGCGTCGTCGACATCTTCACGGACGAGCTCCTC CGTCTGCATCGGGGCCAAGCTTGGGACCTGTACCTGGGCGGGAGA
Appendix 6. List of students supported throughout the extension of the research.
Name Level
Mara Couto
Dr. Montalvo’s Lab
Graduate maracouto777@gmail.com
Gloriner Morell
Dr. Maldonado’s Lab
Graduate glorimorell@gmail.com
Marcia Alayon
Dr. Montalvo’s Lab
Alexandra Benítez
Dr. Maldonado’s Lab
Lorena Cuebas
Dr. Montalvo’s Lab
Tavania Espinosa
Dr. Montalvo’s Lab
Agnes Martinez
Dr. Montalvo’s Lab
Coraly Morales
Dr. Maldonado’s Lab
Miguel Ortíz
Dr. Maldonado’s Lab
Undergraduate (Jan. 2007May 2008)
Undergraduate (Jan.- May 2008)
Undergraduate (Aug. 2006May 2008)
Undergraduate (Jan. –May 2007)
Undergraduate (Aug. 2006May 2008)
Undergraduate (Aug. 2006May 2008)
marcia.alayon@gmail.com
abr23898@uprm.edu benitezalexandra@hotmail.com
lorena.cuebas@gmail.com
None available
agnes.aml@gmail.com
coralymorales@hotmail.com coralymorales@yahoo.com
Undergraduate (Aug. 2006May 2008) miguelortiz02@gmail.com
Roberto Román Dr. Maldonado’s Lab Undergraduate (Aug. 2006May 2008) rorjpr16@yahoo.com
Alitza Santiago
Dr. Maldonado’s Lab
Julia Uzcategui
Dr. Maldonado’s Lab
Undergraduate (Since Jan. 2008)
dance_ali_94_@hotmail.com
Undergraduate (Jan.- May 2008) juliauzcategui@hotmail.com
Phone
Role in research
787 464-4756 1. Resarch on endophytic prokaryotic diversity. 2. Training and supervison of undergraduates.
787 677-3195 1. Research on potential of fungal endophytes from T. testudinum as producers of bioactive compounds.
2. Training and supervison of undergraduates.
None available Prokaryotic endophytic diversity
787 368-3465 Salt physiology
None available Prokaryotic endophytic diversity
787-464-4048 Prokaryotic endophytic diversity
None available Prokaryotic endophytic diversity
787 201-8132 Culture and culture independent identification of fungal endophytes
787 598-8293 Culture and culture independent identification of fungal endophytes
787 238-9950 Culture and culture independent identification of fungal endophytes
None available Interactions among endophytic microflora
None available Salt physiology